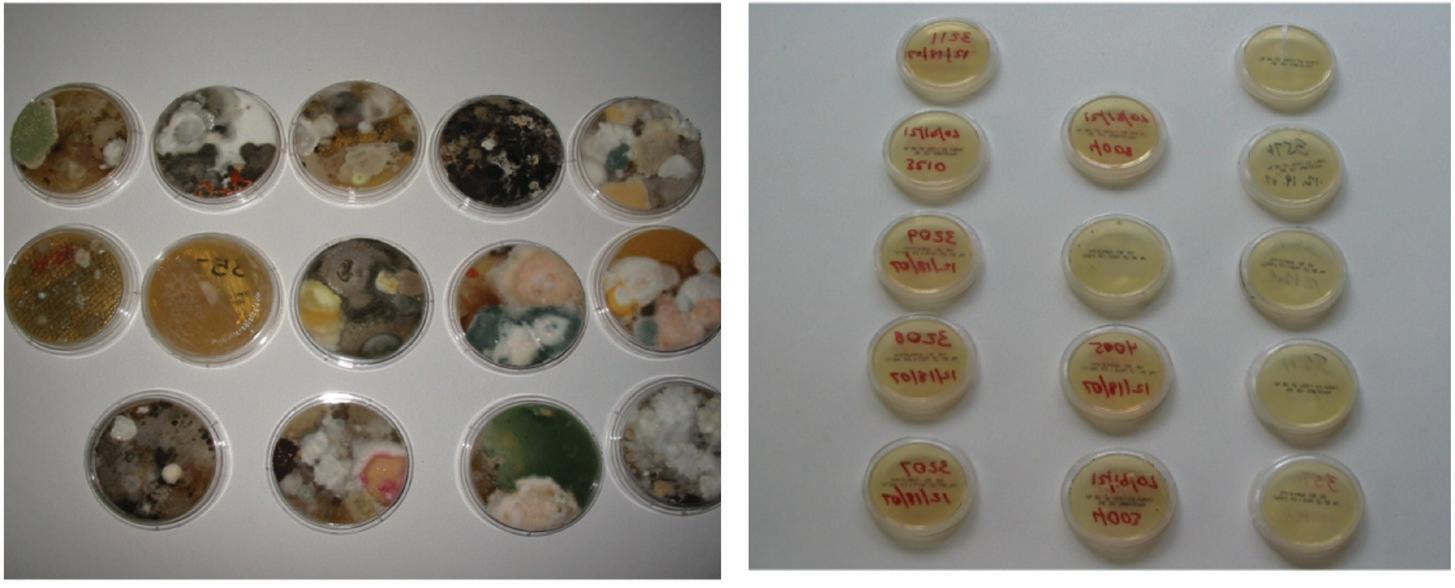

HEALTHCARE FACILITIES PP 100010900 UPGRADING FROM INDOOR AIR QUALITY TO INDOOR AIR SAFETY USING HEAT PUMPS FOR HEADING TOWARDS NET ZERO AIR PURIFIERS IN HOSPITAL AND HEALTHCARE SETTINGS FEATURED INSIDE VOLUME 47 I NUMBER 3 I OCTOBER 2022 TOWNSVILLE UNIVERSITY HOSPITAL SEE PAGE 17
BeaconMedaes is a leading specialist in the design, supply and installation of piped medical gas distribution systems. We proudly play a vital role in hospitals around the globe in sustaining patients when they are at their most vulnerable, such as:



Medical Breathing Air: WSAS LifeLine package unit incorporates oil-free scroll compressors, desiccant dryers, pre, post and carbon filters, lead/lag controls, regulators, and receiver, all on one skid package.

Scan the QR code below for information on our Medical Gas Alarm Panel and Oxygen generators!

Breakthrough technology with BeaconMedaes BeaconMedaes Australia 0429 854 457 All BeaconMedaes solutions comply with Australian standards AS2896-2021.
CONTENTS
REGULARS
3 Editor’s Message
5 National President’s Message
71 News
BRANCH
FEATURE ARTICLES
17 Townsville University Hospital Pharmacy Manufacturing Unit

27 Upgrading from Indoor Air Quality to Indoor Air Safety
35 Using Heat Pumps for Heading Towards Net Zero
43 Proactive vs Reactive Maintenance

47 What are the Advantages of Applying Adiabatic Humidification in a Hospital?

52 The Anatomy of a Decarbonised Medical Facility
55 Air Purifiers in Hospital and Healthcare Settings
57 Hospital Estates Strategy in the Age of Climate Emergency
67 Infection Risks and the Environment
Cover: Townsville University Hospital
IHEA NATIONAL OFFICE
Direct: 1300 929 508
Email: IHEA.members@ihea.org.au Website: www.ihea.org.au
IHEA NATIONAL BOARD
National President
Darryl Pitcher
National Immediate Past President
Jon Gowdy
National Treasurer
Rohit Jethro
Communications
Darryl Pitcher
Membership Registrar
Michael Scerri
Visit the Institute of Healthcare Engineering online by visiting www.ihea.org.au or scanning here →
Standards Coordinator Rob Arian
Directors Steve Ball, Rob Arian, Peter Easson, Adrian Duff
IHEA ADMINISTRATION
Finance Jeff Little Membership Vanessa Gallina: ihea.members@ihea.org.au
Editorial Darryl Pitcher
IHEA MISSION STATEMENT
To support members and industry stakeholders to achieve best practice health engineering in sustainable public and private healthcare sectors.
ADBOURNE PUBLISHING PO Box 735, Belgrave, VIC 3160 www.adbourne.com
ADVERTISING
Melbourne: Neil Muir
T: (03) 9758 1433
E: neil@adbourne.com
Adelaide: Robert Spowart T: 0488 390 039 E: robert@adbourne.com
PRODUCTION Sonya Murphy T: 0411 856 362
E: production@adbourne.com
ADMINISTRATION
Tarnia Hiosan
T: (03) 9758 1433 E: admin@adbourne.com
The views expressed in this publication are not necessarily those of the Institute of Healthcare Engineering Australia or the publisher. The publisher shall not be under any liability whatsoever in respect to the contents of contributed articles. The Editor reserves the right to edit or otherwise alter articles for publication. Adbourne Publishing cannot ensure that the advertisers appearing in The Hospital Engineer comply absolutely with the Trades Practices Act and other consumer legislation. The responsibility is therefore on the person, company or advertising agency submitting the advertisement(s) for publication. Adbourne Publishing reserves the right to refuse any advertisement without stating the reason. No responsibility is accepted for incorrect information contained in advertisements or editorial. The editor reserves the right to edit, abridge or otherwise alter articles for publication. All original material produced in this magazine remains the property of the publisher and cannot be reproduced without authority. The views of the contributors and all submitted editorial are the author’s views and are not necessarily those of the publisher.
1
REPORTS 7 QLD 11 WA 13 SA/NT 14 NSW
43 17 27




EDITOR’S MESSAGE
It is with pleasure we share with you the Spring 2022 Edition of Healthcare Facilities and apologise that this edition has been delayed by a few weeks.
Our cover article explores the Townsville University Hospital, Pharmacy Manufacturing Unit upgrade. QLD IHEA member, Mark Fasiolo explores this project and shares his experience in this state-of-the-art facility. IHEA members often express their appreciation at hearing of technology and improvement projects, whilst also considering lessons learned from articles like this. As Editor I am always keen to hear from members and industry professionals willing to share their experiences with readers.
We also share the IHEA 2022 Perth Conference ‘Best Paper Award’ presented by Dr Normand Brais of Sanuvox entitled ‘Upgrading from Indoor Air Quality to Indoor Air Safety’. Dr Brais was excited to receive the Best Paper Award and shared the recognition with his team.
I was able to attend the recent 2022 IFHE Congress that was hosted by the Canadian Healthcare Engineering Society (equivalent to IHEA). I attended the IFHE meetings in my capacity as an IFHE Executive Board Member and represented IHEA to the 57th Council Meeting. It was a pleasure to share the experiences and networking connections of another amazing national conference. Whilst it had a strong Canadian theme, there were a considerable number of papers presented from IFHE colleagues from
around the world, with a strong focus on sustainability, de-carbonising healthcare facilities, responding to design changes as a result of COVID and a wealth of other important topics.
The IFHE launched an ambitious award project to recognise healthcare facilities around the world for reducing their energy consumption. The closing event of the CHES conference recognised the facilities who had reduced their energy consumption over a two-year period by more than 5%, and also recognised those who achieved a 10% reduction, and awarded “Best in Country” contributions. It was pleasing to see a facility from Perth, Western Australia given this global recognition amongst many facilities from North and South America, South Africa, Europe and the UK.
I take this opportunity to remind our Australian and New Zealand readers about the upcoming NZIHE Conference being held in Christchurch, New Zealand and encourage any IHEA members to consider attending this event. Please visit www.nzihe.org.nz for more information.
As always, I thank our members for their contribution to this Spring Edition of Healthcare Facilities and all of the sponsors and advertisers who have contributed to the excellent content before you.
Regards
Darryl Pitcher – Editor

3 REGULARS

NATIONAL PRESIDENT’S MESSAGE
Iam happy to advise members as we move into Spring, that the member application and renewal processes are now well embedded through the new platform, IHEA Connect, and the IHEA website. I would like to apologise for the long drawn-out process of renewals that were badly impacted by the migration process. In our last journal and at the national conference in Perth in May, a lot had been said about bringing together IHEA Connect and our membership renewal process, through which a number of benefits to members would be delivered including monthly direct debits for member subscriptions.
Hindsight is a wonderful thing, and what was not as clear as it might have been, was the level of complexity in linking our banking system with the online payment interface and establishing communication with the accounting system and the membership portal. Despite our best efforts in robustly testing a ‘sandbox version’, once the production system went live, some settings were not correct causing the renewal process to hit some speed-bumps that required a pause in taking payments. Some members were inconvenienced by these issues, for which I apologise unreservedly. The membership services team have been working hard to resolve all issues this transition created, however if you are still experiencing difficulties please reach out to the team.
I am happy to advise that all processing issues have been resolved and IHEA Connect in both the website version and the mobile application are functioning as intended for membership renewals and new applications. With these delays, the use of IHEA Connect for member notification has been paused, however the recording of learning and development activities is now better than ever. The CPD points have been reset with the 2022 membership renewal cycle, as the two year cycle from initial launch has now
passed. Previous learning activities have been archived and will be available once matched to IHEA Connect
Members are encouraged to capture their IHEA Branch activities, and other professional development activities within IHEA Connect. You can log into the membership system and update your contact details and review your learning progress by clicking on ‘Member Login’ at www.ihea.org.au or on the Android or iOS application available from your devices app store. Remember if you previously installed the old IHEA LDP app, you must delete this and download and install the new IHEA app. If you require any assistance with login credentials or other membership enquiries please email Member Support at ihea.members@ihea.org.au or call on 1300 929 508. There has been a lot of individual communication in resolving the above issues, so please be patient with the team responding to emails and calls.
The 2023 IHEA National Conference details are about to be released – but the short version is that the Conference will be held in Adelaide in late May…keep an eye out for details soon to be shared. We look forward to continuing to support member activities, especially learning and development opportunities and connection with sponsors and organisations that provide services to the healthcare engineering professionals that IHEA represents.
Importantly, members should have received an e-Bulletin advising of a series of webinars and lunch-time meetings being coordinated by the Vic-Tas branch and there is considerable interest from a number of suppliers to promote technology and solutions, compliance and sustainability opportunities through this series of online webinars.
All the best Darryl Pitcher, IHEA National President

5 REGULARS








1300 SAFE Co / 1300 723 326 / www.safeco.tech Nurse Call Duress Real Time Locating Asset Tracking Messaging Reporting
BRANCH REPORTS
QUEENSLAND BRANCH REPORT
It still feels like Winter in Queensland (at least in the South East) but the signs are there of the coming spring!
Mid-Year Conference
The Queensland branch successfully held the Midyear Conference on 14 July and it was well attended with almost 100 delegates and sponsors joining us on the day. The theme this year was: Resilience: Floods, Fires, Pandemics….





A big thankyou to the committee members who helped to organize the event, with special thanks to Brett Nickels, Arthur Melnitsenko and Peter White for undertaking the bulk of the organising. Special thanks also for Matt Smith for stepping in at the last minute to take control of the audiovisuals and working through the technical glitches on the day. As the saying goes, never work with children and animals – now just add IT and technology in general.
This year we unintentionally managed to organise the conference to be held after the last State of Origin – no sign of the tensions boiling over into the conference. One organizer was conspicuously silent on the outcome though.

It is with sadness that we report that Leah White, wife of long-time QLD branch member, Peter White, passed away on Sunday September 4th, after a short illness. Peter has been, and continues to be a significant contributor to IHEA events in QLD, as a member of the QLD Committee of Management and among other things, convenor of the 2009 National Conference on the Gold Coast.
Leah will be remembered by many in the QLD branch and across the country as an active supporter of IHEA activities, and she will be sadly missed by Peter and their family. Our condolences go to Peter White at this time of loss and sadness.
Dave Gray accepting a prize
Schneider Major Sponsor
Delegates at QLD State Conference
Galvin Engineering Major Sponsor
Higgins Major Sponsor
7




Cleveland Compressed Air are the only authorised service representative for ALMiG & BOGE here in WA. Products Include • Medical Breathing Air Compressors • Medical Tool Air Compressors • Filtration • Nitrogen Generation We’re a family owned business with over 30 years of experience. Our clients don’t just get air compressors, they get tailored solutions backed by quality products, audits, installations, service & repairs. CLEVELANDCOMPRESSORS.COM.AU CLEVELANDCOMPRESSORS.COM.AU
A one-day program was trialed this year and it worked extremely well from most reports. Attendees are invited to share any thoughts and feedback on how it went or if there is a preference for a one or two day event in general.
Once again, we were well supported with sponsorship by our local suppliers and consultants. A special thanks for their continued support - especially our major sponsors Higgins and Schneider and our tradeshow sponsor Galvin Engineering.
November/December PD
The committee is planning to hold an afternoon PD late November/early December. Keep an eye out for updates.
Committee of Management
We welcome Nic Coffey and Andrew Leggate to the CoM and look forward to working with them. Special thanks to Brett Nickels for all the roles he has taken over the years and we wish him all the best as he transitions to retirement, and we will continue to lean on him as much we can. Thankyou also to Peter White and Dave Gray for their continued involvement in their own retirement.
Our COM members currently are:
President Danny Tincknell
Treasurer Michael Ward Secretary Matt Smith
Assistant/Interim Secretary Brett Nickels
State National Board Representative Adrian Duff
Committee Member Christopher Aynsley-Hartwell
Committee Member Arthur Melnitsenko
Committee Member David Gray
Committee Member Peter White
Committee Member Mark Fasiolo
Committee Member Mark Collen
Committee Member Andrew Leggate
Committee Member Nic Coffey
Committee Member Matt Smith
If you would like to communicate with the QLD Branch via email, please do so at ihea.qld@ihea.org.au
Hope you all get to enjoy spring without too many calamities.
Danny Tincknell President, QLD Branch
VALE
It is with some personal sadness that we lost one of our Queensland Branch founding members with the passing of Roly Border on 29th July 2022.
Roly was initially part of the Merchant Navy which provided a natural breeding ground for the Hospital Engineers of the day. Roly joined the IHEA as a ‘Member’ on 15th Feb 1974.
He was Supervising Engineer at the Chermside Hospital in Queensland from the late 60’s and what we now know as The Prince Charles Hospital until his retirement.
Roly held several committee positions within the newly formed Queensland Branch, he was well respected and always an active member of the QLQ Branch of the IHEA.

Roly regarded his engineering department the same way as you would a ship at sea.
Consequently, he steered the department from many obstacles and God help anyone who tried to interfere with his judgement and was often seen reminding them of the error of their ways.
On the other side of the scale if you had a problem, he would be right there and if it was within his power he’d sort it, there was always this balance with him and this was what gave the department its sense of stability.
After retiring he kept up his contact with his fellow healthcare engineering colleagues through the IHEA for many years and he is remembered with great affection.
RIP Roly, Our sincere condolences go to Roly’s family and friends.
Roland (Roly) Border 6 May 1932 - Jul 2022 (90 years)
9 BRANCH REPORTS
Better decisions for energy management
Aggressive energy standards and new initiatives tightly regulating sustainability reporting are advancing in tandem with the digitalisation revolution. The result is real-time data-driven energy management solutions.
Organisations that recognise the significance of energy management, will benefit by visualising their energy consumption, tracking and reducing it. ABB Ability™ Energy Manager – whether cloud based or on-site, provides any organisation with the ability to do just that.

ABB designates five functional stages that consti tute essential best practices for energy manage ment, where digital tools play a fundamental role: detect, monitor, analyse, optimise and control. Through detection, facility owners and managers use data from utility bills and available building information to benchmark, virtually disaggregat ing the energy costs to identify areas of excess energy consumption. Large datasets and Artificial Intelligence algorithms support this process.
Once a benchmark is set, monitoring follows. By leveraging device connectivity to visualise the historical and real-time energy data of key assets, facility owners and managers build a clearer picture of the issues to be resolved. Products such as circuit breakers, meters, relays, EV-chargers, inverters and sensors, linked to an on-site connectivity infrastructure or dashboard with widgets, are critical.
Once gathered, data is analysed, especially for Key Performance Indicators (KPIs), and output reports are created, enabling saving actions aligned with benchmark targets. Energy forecasting analytics make this stage easier and more accurate.
Next, asset setpoint scheduling is used to optimise targeted KPIs. Here, smart connected products, power quality converters, uninter rupted power supplies, transfer switching and advanced relays, feed into an optimisation engine, enabling those charged with delivering energy reductions to improve outcomes.
With energy management systems and processes in place, control allows the asset setpoint to be carefully adjusted for energy efficiency or service continuity strategies. Pre-engineered reference architectures with Edge controllers and smart connected products, plus on-site distribution energy resources, microgrids, BESS and renewable technologies, should be considered. By following these stages, organisations can continuously improve energy efficiency practices.
TO LEARN MORE
ABB Ability™ Energy Manager is the digital solution to monitor and optimise your energy consumption and CO2 footprint, giving the chance to make faster and better decisions based on data insights.
Scan the QR code to learn more about smart energy management and how it could help your company.
—
WA BRANCH REPORT

WellWinter is done and dusted, and we move into Spring, the season of new growth, a statement never truer for the Western Australian Committee of Management.

It has been pretty quiet on the Western Front since our National Conference in May. Western Australia has been under the vice like grip of another COVID wave however this time combined with a pretty nasty version of influenza.
These two viruses and the WA Health Department’s RED System Alert and Response (SAR) rating meant that visiting sites, especially Healthcare facilities and indeed just holding branch meetings became near on impossible. Looking back maybe this was a bit of a blessing, as most of our members would have been working seriously hard covering the large gaps in their workforce left by the high staff absenteeism.
Anyway, that was then, and this is now, as Spring dawns our SAR rating has fallen to Blue and avenues are beginning to reopen. It seems Perth is reawakening to a sense of normality.
Early September we are visiting St John of God Hospital Murdoch, where Engineering Manager Mr John Bose will


host a full evening with our annual Special General Meeting, a site tour of their new Radiation Bunker, a professional development session on the challenges of replacing their aged main switchboard topped off with a belated acknowledgement of our Engineer and Tradesmen of 2021.
By the generosity of EcoJemss’ Leif and Tina Jensen, our members will be invited to visit Rosco McGlasson’s workshop early in October to listen to his exploits and to actually see Aussie Invader 5.
At the end of October, we will be venturing 2 hours south of Perth to Bunbury where St John Of God Hospital Bunbury’s Facilities Manager Peter Clifford will host our first country branch meeting.

In November we are looking to venture to Graylands Hospital for a joint presentation from the Campus Facility Manager Simon Marsh supported by Fosters Data and Comms and Schneider Electrics to hear how Graylands installed and is managing their new Electric Vehicle Fleet
We will be holding our annual sundowner at the Hollywood / Subiaco Bowling Club in Nedlands, where our members will once again be able to gather to renew old friendships, meet
11 BRANCH REPORTS
Safety and water control has never been easier. Discover why you should make CliniMix® Lead Safe™ CMV2 your first choice: Learn more at www.galvinengineering.com.au Thermal disinfection without removing front faceplate. Unique hygiene flush feature for in-situ disinfection. Thermostatically controlled water temperature and scald protection. Lead Safe™ materials. Environmentally sustainable solution. Bluetooth, colour and activation options available.
How often is the cool room door left open?
And how much has
Power bills?
Spoiled produce?
Unnecessary Cool room checks?
T-TEC Wireless data logger with a temperature sensor going into the cool room and a door switch sensor can give alarms that can be seen or heard locally and remotely via a phone app. The effect and duration is clearly seen on the graph and statistics.
Contact us for a quote for the TempReport System.
Temperature Technology
105 Anzac Highway, Ashford SA 5035
Tel: 08-8297 7077 Email: sales@t-tec.com.au
new members and bring another difficult year to a close over a few drinks and nibbles.
Speaking of closure, Spring 2022 brings an end to my tenure as State President, a position I have had the honour of holding for the past 3 years. It is now time for me to step aside and to let more adventurous and innovative minds prevail. Over the years I have been ably supported by the best Committee of Management ever. Each have worked tirelessly during the most difficult of times and never once complained when asked to go above and beyond. It is they who deserve all of the credit so to my Vice President - Alex Foster, to my State Secretary - Andrew Waugh, to my State Treasurer - Yuri Deans and to all my Committee MembersJana Simpson, Sarah Bailey, Sue Done, John Pereira, John Bose, Gavin Kinsella, Leif Jensen, Philippe Tercier and Greg Truscott, I give my sincere appreciation and thanks.
Fred Foley President, WA Branch
Let
Patient
We are the electricians of choice for healthcare facilities across WA.
From install & commission to certification & compliance, Foster’s Services is your turn-key solution.
We specialise in delivering medical electrical services for public & private facilities including:
■ Hospitals
■ Medical clinics
■ Day surgeries
■ Allied health
■ Dental
■ Metropolitan & Regional facilities.
9337 3315
E. service@fosters.net.au
W. www.fosters.net.au

12 BRANCH REPORTS
Are your Clinical Areas Compliant? GOLD MEDICA L ELECTRICA L SPECIALIST S EV CHARGING SOLUTION S P. 08
? ? ??
Treatment Areas (including Body & Cardiac Areas) must be tested annually & meet Australian Standards.
us take care of your electrical compliance needs & ensure your patients & staff are safe.
that cost you?
SA/NT BRANCH REPORT
Wherehas the time gone, this report from our SA/NT branch acknowledges the end of another financial year and it really does seem like if we blinked, we would have missed it. Now we start our 2022-23 year, and our committee looks to hit the ground running. We are very excited for this year with all roads heading towards our National Conference being held in beautiful Adelaide in May 2023. Our branch sub-committee are well underway with the planning and organisation for the conference in collaboration with the team from Iceberg Events. We will be sharing more details for this event soon and very much look forward to seeing many of you here in May 2023.
Recent events
On July the 21st we held a professional development event hosted by Enware in their Kent Town S.A. showroom highlighting their Thermostatic Mixing Valves and the technology integrations that they have implemented to make compliance for infection control easier for facilities managers. The presentation was followed with an excellent networking opportunity with first class catering provided by our very generous hosts. We would like to extend our thanks to the Enware team for their amazing hospitality on the night.
Following the Enware presentation we held our SA/ NT Branch State Special Meeting where nominations and appointments for the 2022/2023 committee were tabled and accepted as per the table below. Adam Walding from the Northern Territory has left the committee but has been replaced with Neil Bond as his successor and continuing the NT representation on our committee. South Australia committee member Max Sankauskas has resigned from the committee. We thank Adam and Max for their contributions over the past 12 months and look forward to welcoming Neil to the CoM. Michael Scerri has stepped down from the State President role and continuing on the CoM and as well as maintaining a role on the national committee. Thank you, Michael, for your stewardship over the last few years and looking forward to your continued contribution for the benefit of the industry and members of IHEA. This committee looks forward to the year and an exciting National Conference in Adelaide.
COMMITTEE OF MANAGEMENT 2022-23
President Andrew Russell Vice President Gary Clifford
Treasurer Daniel Romeo
Secretary Daniel Romeo
State National Board Rep Michael Scerri
Committee Member Darryl Pitcher
Committee Member John Jenner
Committee Member Richard Bentham
Committee Member Neil Bond (NT Rep)
Committee Member Damien Breen
Upcoming events
Event Description
IHEA members are invited to attend this informative presentation which will provide collaborative technology workshop to understand:
• What you are trying to achieve as a hospital
• What types of technology are you keen to explore
Section 1 – Discovery session
Section 2 – Explore KONE Technologies
Digitally Connected Elevators and capabilities they unlock Ecosystem Partnership = possibilities Digital Experience Elevator
Destination Control Specific elevator functions for hospitals
This Professional Development event will be rounded out with networking drinks afterwards.
More details to be sent soon via email on the IHEA website.
In October we are hoping to hear from the consortium managing and maintaining the world-leading Royal Adelaide Hospital, Celsus. They will lead a panel discussion on environmental social governance and compliance. The panel will also include perspectives from Mott MacDonald and AMP.
For November we are planning a networking opportunity for facilities engineers and managers to meet vendors and suppliers where new products and services can be showcased to our members and guests. We are anticipating tying this onto an end of year/Christmas social event. More to come on this one also.
Communications via the SA/NT branch email addressihea.sa@ihea.org.au.
Andrew Russell President, SA/NT branch
13 BRANCH REPORTS
BRANCH REPORTS
NSW/ACT BRANCH REPORT
Welcome from the NSW/ACT IHEA Branch committee for 2022-23.
I’d like to start my first contribution to Healthcare Facilities, by introducing myself. I am Cameron Ivers from ACIA Electrical Services Pty Ltd, and I am an electrical contractor who has been working in the healthcare industry for more than 20 years.
I have been on the Committee of Management for the NSW/ACT Branch for some time and have been actively involved with Professional Development days, conferences and supporting the IHEA. I have recently been appointed to the role of NSW/ACT Branch President and will be actively working towards PD days, training and asking questions.
As we all are just recovering from the heavy challenge of the last few years of the COVID pandemic, and getting outside for a bit of fresh air, I hope everyone one is getting back to the new normal.
The period placed a massive strain on everyone in the health services industry and we were all put to the test. In my view, from what I saw and experienced, everyone stood up and took the fight to the battle, leading with the front foot. Everyone who worked on that front line for those intense months and years should be proud of what was achieved. From those pop-up sites, to completely changing wards, building numerous isolation wards, erecting vaccine hubs, and everything else thrown in. With the added pressure of having to make it happen overnight!
I hope everyone has booked in a long holiday…
Now that a lot seems to have “normalised”, the NSW/ ACT committee would like to start getting professional development days going again and also start looking towards a State conference for next year.
We are intending to follow on from the 2020 IHEA National Conference and having a site visit to Concord Hospital redevelopment led by CoM member and Past National President Jon Gowdy. So please save the date for Oct 7th 2022. More to come.

We also need your help.
Could our members start talking to your up-and-coming team members and staff to explain to them what the IHEA stands for and how being a member can help. We will be organising industry leaders, suppliers and experienced facility managers to be available for PD days. Being involved and hearing what people have to say, but also being able to ask those question and getting answers back. In my view it’s a win- win for everyone.
Let’s all worked together and get these events rolling again and catching up.
Kind regards
Cameron Ivers
President, NSW-ACT Branch
The NSW/ACT Branch can be contacted via email at ihea. nswact@ihea.org.au
14
Disinfection through the power of light
UV-C Solutions for contamination control and surface treatment whilst people are present
Ultraviolet technology is a non-chemical approach to disinfection which has a number of key benefits:

UV-C light is an environmentally friendly, effective and efficient way to create a germ free environment for patients, staff and visitors.
UV-C disinfection lighting effectively inactivates 99.99% of viruses and bacteria in the air, on surfaces and objects

UV-C Devices are easy to use and require low maintenance
Contact us today to start creating healthier environments in your facility www.cleanairwa.com.au 1300 029 141


IT’S IN OUR DNA.
From design to manufacture, from consultation and installation to ongoing service support - quality, efficiency and reliability are inherent qualities in everything we do at KAESER Compressors. That means when you choose KAESER to be your compressed air partner you can be assured that you’ll be receiving a premium quality, ultra-efficient, extremely reliable and clean compressed air solution that has been tailored to meet your precise compressed air requirements.
Quality. Efficiency. Reliability. At KAESER Compressors it’s in our DNA!
1800 640 611

au.kaeser.com
KAESER HP_Healthcare Facilities_Autumn_Winter_Spring 2022.indd 1 17/12/2021 5:05:57 PM




CENTRAL MONITORING AND CONTROL PANELS FOR MEDICAL STAFF LINE ISOLATION MONITOR FOR ISOLATED POWER SUPPLY Represented in Australia by CapTech 1300 280 010 | bender@captech.com.au www.captech.com.au • All important information available at one location • Clock, timer, countdown timer • Monitoring of medical gases • Control of surgical lights and operating table • Control of room temperature, humidity and light • Monitoring of UPS and isolated power supply • Visual and audible alarms • Monitoring of the prospective hazard current • Test module to meet the requirements of AS/NZS 4510 • Insulation faults location without interrupting power supply • Monitoring of transformer load and load of individual circuits • Visual and audible alarms MAKE YOUR OPERATING ROOM READY FOR THE FUTURE
TOWNSVILLE UNIVERSITY HOSPITAL PHARMACY MANUFACTURING UNIT
By Mark Fasiolo (BE (Hons), RPEQ, MIEAust CPEng, NER)
The Townsville Hospital & Health Service (HHS) has recently completed the installation of a new state-of-the-art Pharmacy Manufacturing Unit at the Townsville University Hospital (TUH). The $6.75M project included the refurbishment of an existing shell space to house this new 165m2 pharmacy cleanroom suite as well as the construction of a new dedicated rooftop plantroom to house the supporting services infrastructure. This article will review the project from a healthcare engineering perspective, focusing on key design and construction management outcomes.
What is a Pharmacy Manufacturing Unit?
Pharmaceutical manufacturing is an area of healthcare that not many people know about, but without which we couldn’t deliver some of our most critical services. This new Pharmacy Manufacturing Unit (PMU) cleanroom at TUH manufactures medications that allow the most unwell North Queenslanders to be cared for locally and closer to home. The cleanroom produces about 5000 medications a year for patients requiring bone marrow transplants, oncology treatment, clinical trials, auto-immune conditions and intensive care. Medications produced in this cleanroom can have a ‘shelf life’ of as little as one hour which means the only way to administer them to patients is to produce them on site. Without this facility hundreds of regional patients would have to travel to their nearest capital city (Brisbane in this case) for care, sometimes with significant wait times. The cleanroom also played a critical role in the fight against COVID-19 with a dedicated team producing life-saving medicines, such as Sotrovimab, on site here in Townsville.

The new facility is a completely sterile, HEPA filtered and pressure-controlled cleanroom suite to protect the integrity of the products and to safeguard the manufacturers. It has three dedicated manufacturing rooms where the different drugs are made – a cytotoxic cleanroom, aseptic cleanroom and an isolator room. Each manufacturing room comprises of relevant safety cabinets and/or isolators where the medications are made, along with airlocks and anterooms that staff need to sequentially enter to put on the relevant personal protective equipment. Once the products are compounded, they are placed through filtered pass-through hatches separating the workspace from the main cleanroom before being distributed to the treating team and the wider hospital.

Project Initiation & Scoping
The PMU construction project was a complex project undertaken over several years. As the quantity, complexity and scope of the drugs required to be delivered by TUH had
Figure
Floorplan
17 FEATURE ARTICLES
Figure 1: PMU Isolator
2: PMU
Layout (BMS Touchscreen)
FEATURE ARTICLES
changed drastically in the past decade and the governing standards and codes requirements were updated, the existing 15-year-old manufacturing suite was fast becoming unfit for purpose and no longer compliant with contemporary medicine requirements. In response to these identified issues, the THHS Pharmacy Department commissioned a review of the existing manufacturing suite through a Gap Analysis Report prepared by Asia Pacific Consultants Pty Limited (APC) in 2015. This report reviewed the existing facility design and operations against the current accepted standards and practices applicable to cleanroom facilities and made recommendations to address the non-conformances identified. The key specific standards and guidelines governing cleanroom design and operation include (but are not limited to):
• PICS Guide to Good Manufacturing Practices for the Preparation of Medicinal Products
• Therapeutic Goods Association (TGA) Standards

• ISO 14644 suite – Cleanrooms and Associated Controlled Environments,

• AS 2252 suite – Cabinets and Cleanrooms - Design, Construction, Installation, Testing and Use, Although several short-term improvements were identified and implemented, this gap analysis ultimately identified that


most of the improvements required were significant in nature and a refurbishment of existing cleanroom suite in-situ was not possible. The key non-conformances centered around (a) the lack of established room environmental particle monitoring and dedicated temperature and relative humidity control (b) the lack of steps in cleanroom grades (and relevant room pressures) between uncontrolled areas and manufacturing rooms. With no alternative manufacturing facility to cater for the community in North Queensland, managing continued operational serviceability was a key driver in the determining how and where the existing PMU suite would be upgraded. Hence it was decided that a completely new manufacturing suite was required to be constructed in a different location within the hospital to comply with these new requirements and allow the space to accommodate for the future expansion and growth of medication services expected within Townsville HHS.
As well as complying with all the aforementioned standards and codes, this new TUH PMU suite also needed to be built to comply with the Therapeutic Goods Association (TGA) Standards. This was to ensure that the TUH could apply for, and obtain, a TGA manufacturing license to allow for bulk
Figure 3: Cytotoxic Medication Manufacturing
Figure
18
4: PMU Construction - AHU Installation RPA Architects are proud of their involvement with the new Pharmacy Cleanrooms at the Townsville University Hospital • Principal Consultant • Architectural Design & Documentation • Construction Stage Services 112 Denham Street, Townsville (07) 4772 1055 RPA@rpaarchitects.com
FEATURE ARTICLES
















manufacturing and on selling of drugs if, and when, required to service the wider regional Queensland.
Project Team
The Principal Consultant engaged for the project was RPA architects and the services consultants included Ashburner Francis, Parker Hydraulics and Northern Consulting Engineers. APC consultants were also engaged as an independent subject matter expert to assist the Townsville HHS and design team in developing a preliminary design, performance brief and budget costings as well as reviewing proposed designs solutions for compliance with applicable standards. The design of the new suite commenced in 2016 and had many iterations before the final solution was settled on and agreed.
In early 2020, Paynters were awarded the construction contract and the project was constructed and commissioned over an 18-month period. This was the first manufacturing unit the design and construction team had been involved in and it was a steep learning curve for most involved due to the governing standards and design tolerances being some of the most stringent any project team would face. Because of this complexity, the Townsville HHS also decided to extend
APC Consultants engagement through the construction, commissioning and validation stages to further guide the team through the project and to act as a quality control measure to ensure a successful outcome.
Design Inclusions
The project was highly complex in every aspect and involved several specialised design inclusions and techniques to achieve the desired outcomes. To address the environmental monitoring requirements for the cleanroom, two stand-alone systems were used: an Environmental Monitoring System (EMS) and a Building Management System (BMS). The EMS installed was a stand-alone specialised system (manufactured by Particle Measuring Systems) and was used for the routine microbial particle air monitoring services within the cabinets and the cleanrooms themselves. The existing sitewide BMS (manufactured by Schneider Struxureware) was extended into the new cleanroom facility to control, monitor and trend all other environmental parameters, including pressure, temperature and humidity. The EMS was also connected through our onsite engineering network to the BMS to display read-only particle monitoring values on the BMS for remote monitoring and alarm purposes. These two environmental
icons
denote cipline a r piece of s to. Only and colours in business s, designs, s and CVs.
These icons denote which discipline a consultant or piece of work relates to Only these icons and colours may be used in business cards, reports, designs, fee proposals and CVs






Icon Discipline icons
Our services include:































Icon Discipline
Electrical Mechanical Hydraulic
These icons may also be used in marketing material with these or other approved colours
Ashburner Francis are professional building services consulting engineers with over 45 years’ experience as specialists in the health and aged care sector throughout QLD, NSW, NT, WA, PNG, and the Pacific Islands.








These icons denote which discipline a consultant or piece of work relates to. Only these icons and colours may be used in business cards, reports, designs, fee proposals and CVs.

Some of our health projects include:
• Royal Darwin Hospital Chemotherapy Wing & Cyclotron Building
• Royal Darwin Hospital Main Entry & Outpatient Developments
• Darwin Private Hospital Nurse Call System Replacement

These icons may also be used in marketing material with these or other approved colours
Mechanical
• Prince Charles Hospital Paediatric & Emergency Ward
• St Andrew’s Hospital Toowoomba EndoAlpha Operating Theatre
These icons may also be used in marketing material with these or other approved colours



• Mackay Base Hospital Outpatient Facility
• Bowen & Moranbah Hospital Capital Infrastructure Planning Studies
• Toowoomba Hospital Operating Theatre Suite Upgrade & New Theatre 7
• St Andrew’s Hospital Toowoomba Cancer Care and Radiation Therapy Centre

Manufacturing Unit
• Toowoomba Hospital 3 Tesla MRI Facility
19
PROUDLY ASSOCIATED WITH Townsville University Hospital Pharmacy
Mechanical
icons Electrical
Hydraulic ECR
03 Hydraulics
ECR
03 Energy s
n pline
Electrical Mechanical Hydraulic ECR
03 Electrical Electrical echanical Hydraulic ECR These icons may also be used in marketing material with these or other approved colours 03 Brisbane, SE QLD & NSW Darren Cardy 07 3510 8888 Toowoomba & SW QLD Brian Kenny 07 4512 6070 North QLD Wayne Benson 07 4722 4333 NT/WA/SA Graham Heaslip 08 8942 0585CONTACT
CHILLERS & HEAT PUMPS
THE TRUSTED SOLUTION FOR MEDICAL TECHNOLOGIES

Products which always work, everywhere
MTA chillers perfectly match medical application needs, ensuring a worldwide acclaimed solution offering tried and tested reliability levels.
The TAEevo’s innovative evaporator-in-tank configuration guarantees steady process fluid temperatures mium quality componentry and precise individual factory testing minimizing the risks of unplanned stoppages.

Fail-safe cooling for medical technologies

MTA systems are applied in modern medical facili ties, including imaging and oncology technologies for the cooling of MRI, LINAC and PET machines.

Medical processes and facilities, including computed and magnetic resonance tomography, lithotripsy, lasers and X-rays, require consistent operating safety and thermal precision ensuring image quality, safe functioning and human comfort.


Medical Processes
Healthcare Facilities
Multiple solutions to all your needs
MTA offers air and water-cooled chillers and heat pumps in the 2-2,000 kW range with scroll-inverter, scroll, multi-scroll and screw configurations.
iPNG: chillers with inverter driven screw compressors up to 1,383 kW cooling capacity. , fail-safe engineering, robust quality

Close at hand since 1999, with local stock
MTA’s long-standing direct local presence, with thousands of units installed all over Australia, is the assurance of rapid regional support.
Swift product and spare parts delivery directly from our warehouse. Over 30 nominated qualified refrigeration service centers, with 24/7 response, provide excellent after-sales support nationwide
Air Conditioning
Pakenham VIC 3810 Tel. +61 1300 304 177 E-mail: sales@mta-au.com MTA Australasia Pty Ltd www.mta-au.com PRECISION
FEATURE ARTICLES
monitoring systems are key systems for validation of medications produced as well as the ongoing certification of the suite itself. Visual and audible alarms were installed within the suite to alert pharmacists if any of the environmental conditions fluctuate out of range to ensure the highest level of quality control during manufacturing.




HVAC design - The design of the mechanical HVAC services serving this suite were incredibly complex. Differential pressure gradient control, complex supply and exhaust systems, system redundancy, spill mode operations, fire mode operations, maintainability and testing of all plant, and ‘pre-programmed staged shut down sequences’ for planned maintenance purposes to minimise unnecessary internal suite cleaning regimes were all unique components for this project design and required significant detailing and consideration. Being completely automated in every aspect, the ultimate success of this system design and operation was very heavily reliant on the BMS control strategy to maintain airflows and environmental conditions within tolerances under almost all circumstances.
HEPA filter installation – Another detailed component of the design involved the locations of the HEPA filters within the suite. As with most projects, all terminally mounted HEPA filters within the suite were required to be accessible for ongoing testing and recertification. However, the terminally mounted exhaust HEPA filters within the cytotoxic cleanroom posed the most difficult challenge for the project team. These filters were required to be carefully located and coordinated with the Cytotoxic drug safety cabinets (CDSC’s) located within the room to ensure they ‘completely’ captured the cabinets toxic airflow discharges, whilst still allowing for safe and adequate maintenance access to conduct the required ‘scan testing’ at the filter face as per the Australian Standards. Significant discussions with key stakeholders surrounding accessibility and multiple shop drawing revisions were required during construction to settle on a final solution. Smoke testing was conducted during the final stages of commissioning to validate the effectiveness of the terminal units and even some ‘last-minute’ tweaks to the terminal unit itself with capture hood surrounds were required to ensure all requirements were met.
 Figure 6: (a)
Final Exhaust HEPA Terminal Installation in Cytotoxic Cleanroom; (b) HEPA Terminal Shop Drawing
Figure 5: (a) BMS Screenshot; (b) Visual Alarms (BMS & EMS); (c) EMS Screenshot
Figure 6: (a)
Final Exhaust HEPA Terminal Installation in Cytotoxic Cleanroom; (b) HEPA Terminal Shop Drawing
Figure 5: (a) BMS Screenshot; (b) Visual Alarms (BMS & EMS); (c) EMS Screenshot
21
FEATURE ARTICLES
Plantroom Design – The size and location of the plantroom was key to the success of the project. The plantroom ended up being almost as large as the cleanroom suite itself (approx. 150m2 and 5m high) and was located directly above the suite – and in hindsight needed to be even bigger. A significant amount of plant was required to serve the suite including air handling units, a dedicated preconditioner (for year-round humidity control), numerous exhaust fans (located in 2 x dedicated smaller chambers within the larger plantroom due to the potentially noxious discharges being exhausted), heat pumps, in-slab fire dampers, VAV’s (variable air volume units) for airflow control, switchboards, circulation pumps and all the relevant controls required to operate the plant. Due to the criticality of the suite, and to ensure the suite could automatically switch over and continue to operate in the event of a plant failure, all systems were installed with N+1
fans making the units larger in size than normal. Another key aspect of the design was that all maintainable plant items were to be located within the plantroom to minimise the need to ever enter the actual cleanroom suite for normal maintenance purposes.




HVAC Workshop - Due to probity reasons, the Townsville HHS and design team were limited in how much discussion could occur directly with the BMS control system vendor. Therefore, at the start of construction when all subcontractors had been finalised, the Townsville HHS held a “HVAC workshop” with all stakeholders (design team, builder, mechanical subcontractor, and BMS contractors/engineers). This workshop was to go through the system design from a buildability perspective, iron out minor HVAC RFI’s that they had identified during tender and to fine tune the control solutions, with emphasis on the differential pressure control.
 Figure 7: (a)-(c)
Various Plantroom Equipment; (d) Differential Pressure Room Sensors; (e) Exhaust Fan Chamber #1
Figure 7: (a)-(c)
Various Plantroom Equipment; (d) Differential Pressure Room Sensors; (e) Exhaust Fan Chamber #1
22
FEATURE ARTICLES







 Figure 8: Building Pressure Test - Testing Setup
Figure 9: Rooftop Plantroom Construction
Figure 10: Mechanical Air Balancing Commissioning
Figure 11: (a) Documentation Workroom & Refrigeration Storage; (b) Prep Sterile Room; (c) Aseptic Cleanroom; (d) - (e) PMU Operational Staff
Figure 8: Building Pressure Test - Testing Setup
Figure 9: Rooftop Plantroom Construction
Figure 10: Mechanical Air Balancing Commissioning
Figure 11: (a) Documentation Workroom & Refrigeration Storage; (b) Prep Sterile Room; (c) Aseptic Cleanroom; (d) - (e) PMU Operational Staff
23
FEATURE ARTICLES
VAV’s were ultimately adopted in lieu of barometric dampers for airflow control as a result of this meeting, which was proven to be a fortunate decision during the commissioning phase of the project. This workshop ended up being very beneficial to the success of the project as it minimised the potentially extensive number of RFI’s being generated and gave confidence to the HVAC design and construction teams that the systems could be installed and meet the required building performance with the ultimate level of flexibility and adjustability.
Construction Challenges
Several unique construction challenges were also faced on this project. With very tight pressure gradients and tolerances required in the final build, the building seal was of paramount importance. For this reason, a number of building pressure tests were documented in the design specifications. These tests had prescribed max allowable leakage rates to test the tightness of the ‘envelope’ of the facility and were scheduled at key stages of the project build (outer envelope, and again after all services penetrations). Meeting these air leakage rates was not easy and were the responsibility of the builder and its subcontractor teams. Several bespoke sealing methods were used to ensure that sheet joins, wall penetrations, service
runs, windows, doors and the like were all maintaining the air tightness required in the specification.
Another build challenge faced was the Roof Replacement Methodology. The rooftop plantroom design required the removal of a portion of the existing roof structure in a live hospital facility during the tropical north Queensland wet season. Paynters managed to construct the new roof structure over the top of the existing roof prior to its demolition and removal. This ensured an amount of protection was maintained during construction and considerably reduced the impact of water ingress into the facility.
As was to be expected, by far and away the most difficult and time-consuming component of the build was the mechanical services commissioning. Due to the complexity of the build, a detailed commissioning plan was developed (which included all service trades) to identify and schedule the required commissioning tasks applicable to the build. Building pressure testing, duct leakage testing, continuity testing of electrical and control system wiring, air and water balancing, HEPA testing, Spill mode testing, fire mode operations, noise level testing, etc were all included. An independent NEBB specialist commissioning agent was also employed on the project as a quality control initiative to assist with and validate the commissioning testing results to ensure the design


24
SERVICES GMP Compliance Engineering Services Quality Systems (ISO & GMP) Validation & Qualification Project Management Quality Auditing GMP Training INDUSTRIES Pharmaceuticals Pharmacies and Radiopharmacies Laboratories Blood & Tissue Banks Medical Devices Medical Cannabis APC is here to support your business across Australia and Asia www.a-p-c.com.au Offices in Australia and across the Asia-Pacific region + 61 2 9420 4951 info@a-p-c.com.au
specifications were being met for this finely tuned system. Despite all the prior planning, commissioning difficulties were still experienced when trying to achieve the required pressures gradients and air change rates with such tight tolerances –to the point where a third-party commissioning advisor was called upon to provide innovative balancing solutions which were developed after years of delivering similar facilities across the world. One unforeseen issue that was encountered on this project was that one specific room in the suite was experiencing short sharp dynamic pressure fluctuations of ±10Pa (despite the plant control not changing). The issue was finally identified to be a result of the very high air-change rates in such a tightly sealed room which was causing the system to ‘hunt’ uncontrollably. A tweak was made to the design airflows to the room using the VAV’s to reduce them down to the point where the pressure fluctuations disappeared. This last-minute change was able to be made relatively easily as a result of the installed system design. Despite the challenges, the mechanical HVAC system was commissioned successfully in June 2021 and has been operating without issue since.
The final phase of the project saw the facility undergo a third-party NATA cleanroom certification. This entailed additonal air leakage tests, mechanical system checks, lighting level checks, smoke testing of various equipment

installed, and overall facility compliance to ensure it is ready for use and compliant will all relevant standards and codes.
Conclusion
With so many intricate components to the design, construction and commissioning of this project which needed to fit and work together seamlessly, made this the most exciting, challenging and rewarding project to be a part of. Although at times it was a difficult journey the project was a huge success and is a testament to the efforts and dedication of the project team, contractors and stakeholder groups who assisted along the way. This new state-of-theart TUH Pharmacy Manufacturing Unit is the first of its kind in regional Queensland and aligns with the organisation’s strategic vision to be the leader in healthcare, research and education for regional Australia. This PMU will enable further medical research and innovation into new treatment options at TUH, attracting exceptional pharmacists to the region and improving healthcare outcomes for the community. This TGA compliant pharmacy manufacturing unit also allows the TUH the option to bulk manufacture and on sell specialised medications if/when required to service regional Queensland for many years to come.
Don’t Settle for Less
Manufactured in Australia, the Room Air Purifier (RAP) provides clean, fresh air to immediately improve indoor air quality, particularly in high-density commercial areas. The RAP is designed to continuously cycle air through a HEPA filter and MERV 8 pre-filter to eliminate >99.97% of dust particles, germs, and contaminants

25
LEARN ABOUT THE RAP AT WWW.HOLYOAKEPUREAIR.COM OR CALL 1300 456 962
Mitigate risk and ensure compliance in your healthcare facility.

Mitigate risk and downtime for your healthcare facility through proactive maintenance of HVAC, Fire and Electrical systems. Regular servicing will help to eliminate and spot any potential problems before breakdowns. At Grosvenor Engineering Group (GEG), we understand that the comfort of patients and doctors is paramount in hospitals and clinics. The reliable operation of cooling equipment supporting critical MRI and other medical equipment cannot be compromised.
At GEG, we have over 25 years’ experience providing end-to-end solutions to many healthcare facilities. Our technicians proactively maintain operational technical assets, ensuring your patient-care continues as usual.

HVAC | Fire | Electrical | Advisory | PropTech
www.gegroup.com.au
Ensure power supply reliability Protect people, patients and property Be ready in case of an emergency
VOTED BEST PAPER AT THE 2022 IHEA PERTH NATIONAL CONFERENCE
UPGRADING FROM INDOOR AIR QUALITY TO INDOOR AIR SAFETY
 Dr. Normand Brais Eng., M.Sc., Ph.D.
Dr. Normand Brais Eng., M.Sc., Ph.D.
1 What have we learned from the COVID-19 pandemic?
On March 29, 2022, the White House Office of Science and Technology Policy held an online discussion with experts on cleaning the air not only for COVID-19 but for other infectious diseases as well and for overall indoor air quality. One point all the experts agreed on is that health authorities really missed the boat two years ago by focusing on surfaces instead of airborne transmission. Joseph Allen, an associate professor at the Harvard T.H. Chan School of Public Health and co-author of the book Healthy Buildings: How Indoor Spaces Drive Performance and Productivity, laid it out:
“Because we focused on surfaces, that led to the control strategy of cleaning doorknobs, cleaning elevator buttons, people cleaning their groceries. That was a big mistake. It all flows from airborne transmission…We have to remove the virus from the air. We can move it out of the building through ventilation. We can clean it out of the air through filtration. We can inactivate it through germicidal UV light. It is really that simple.”
Allen further addressed how buildings are designed for bare minimum standards, not for health-based standards, and that “the standard that governs ventilation in your coffee shop, your school, your office, your home” is designed for “acceptable” indoor air quality. “I don’t know about you, or anybody else,” Allen said, but “I do not want acceptable air quality I want healthy air quality or optimal indoor air quality.” He highlighted the fact that “we have choked off the air supply in our buildings for decades. We have got a virus that spread nearly entirely indoors and that sets us up for this massive problem.”
To tackle these unhealthy indoor environments, Allen recommends “tuning up” or, “commissioning,” a building to improve overall air quality, as well as improve energy efficiency. As part of such an initiative, cleaning the air “is great for COVID,” but, he notes, “there are many other benefits here.” To that point he addressed schools, in particular. His team conducted a study a couple of years ago called Schools for Health that showed that “the school
building influences student health, student thinking and student performance.” In short, the better the air quality in a building, the better students’ health, cognitive abilities, and school performance.
About airborne transmission
Given the long settling time of small aerosol emitted when we talk, sing, or yell, contaminated droplets can float in the air for hours and contaminate others. Fig.1 shows the falling time for 1.5 meter height for various aerosol sizes (0.5 to 10 microns) in still air and for large visible sneezing droplets of 100 microns.
Despite the dose-response for SARS-CoV-2 being unknown and continued scientific debate about the dominant mode of transmission, evidence supports that SARS-CoV-2 is primarily transmitted from the exhaled respiratory aerosols of infected individuals. Larger droplets (>100 μm) can settle out of the air due to gravitational forces within 2 meters, but people emit 100 times more quantity of smaller aerosols (<5 μm) in increasing order of magnitude by breathing, talking, singing, and yelling.
2 How to improve buildings’ bio-safety?
To improve indoor air quality we need to move toward biosafety. All the experts recommended improving ventilation and filtration, but they also recommended germicidal UV as a

 Dr Normand Brais pictured with the IHEA Best Paper Trophy.
Dr Normand Brais pictured with the IHEA Best Paper Trophy.
27 FEATURE ARTICLES
FEATURE ARTICLES
well proven technology for preventing the spread of infectious disease and improving indoor air quality, “it really is that simple,” as noted in Allen’s statement, above, but they also recommended UV with a crucial caveat, and we could not agree more that it needs to be a properly sized UV system and that it has been correctly installed. Let’s look at the ABC steps of building bio-safety improvement.
A) Dilution by ventilation
Bringing in clean outdoor air is the first obvious solution to improve indoor bio-safety.
Ventilation strategies that bring in more outdoor air help to reduce viral concentration and therefore lower the risk of people inhaling them. However, to reduce energy cost the
last fifty years have seen a major trend toward reducing the ventilation rate in all buildings, thus making the ventilation option quite limited to improve indoor air bio-safety.
New buildings are often constructed to seal air in for energy efficiency, so their HVAC systems must be on to insure air renewal. Older buildings may be less well sealed, but have outdated air handling systems, or lack air handling systems altogether.
B) Air filtration
Historically, air filters were first introduced in HVAC to protect fans and coils from dust fouling. The fact that it also improves the indoor air quality for the occupants is just an aftermath that was understood much later. Filtration is a great tool to supplement ventilation, or to use if adequate ventilation isn’t feasible, for example when extreme outside temperatures, wildfire smoke, or outdoor pollution make you not want to open a window. Using high-quality air filters like MERV-13 connected to capable HVAC systems or portable air purifiers to remove particles from indoor air is also important. Due to their much higher pressure drop, HEPA filters cannot be easily retrofitted. On a cost basis there is a diminishing rate of return on the reduction of the probability of infection with an increase in filtration as shown in Fig.2.3
In dry environment where the small aerosols can quickly evaporate, because of its small size of about 0.1 micron, only 30% of the SARS CoV-2 viruses can be captured by a MERV13 filter (Fig.3)

C) Air disinfection with UVGI
By inactivating airborne microorganisms with ultraviolet germicidal irradiation (UVGI) systems, we can add another layer of protection in indoor spaces.
Adding UVGI system with a proper dosage can adequately complement the filtration process by deactivating (killing) the microorganisms that are not captured by the filter.(Fig.4)
For instance, one study demonstrated that when used with proper ventilation, UVGI is about 80% effective against the spread of airborne tuberculosis, equivalent to replacing the air in an indoor room up to 24 times in an hour. 4
Used along with layered prevention strategies recommended by Centers for Disease Control and Prevention, and others, improving indoor air bio-safety is a critical part of a plan to better protect us all.

28
Fig.2 Filtration upgrade -vs- airborne disease transmission risk Fig.1 Aerosol settling time and airborne transmission



Controlled Environments Accreditation No.15597 LEADERS IN INDOOR ENVIRONMENTAL RISK MANAGEMENT PRODUCTS AND SERVICES CONTACT OPIRA NOW SOLUTIONS@OPIRA.COM.AU www.opira.com.au 1300 157 969 Ð Continuous Air Disinfection to reduce airborne microbials and VOC’s. Ð 99.9% disinfection of Influenza A, Measles, Tuberculosis, Varicella and other airborne viruses. Ð 99.9% disinfection of SARS-CoV-2 virus that causes COVID-19 disease in a single pass of air. Ð Reducing the risk to Patients, Hospital staff and Maintenance personnel. Ð Reducing the risk of Hospital Acquired Infection (HAI) Ð Providing safer indoor environment. Ð OPIRA IS THE EXCLUSIVE SANUVOX DISTRIBUTOR IN AUSTRALIA WE HAVE A TEAM OF QUALIFIED SCIENTISTS AND A NATA ACCREDITED LABORATORY ARE YOU DOING ALL YOU CAN TO KEEP YOUR PEOPLE SAFE? UV DISINFECTION WILL! BRISBANE | MELBOURNE | PERTH | SYDNEY Dr Normand Brais P.Eng., M.Sc., Ph.D. CTO - Sanuvox
FEATURE ARTICLES
Because it acts to directly disrupt DNA and RNA to prevent their replication, UVGI is effective on every known microorganism. Unlike chemical disinfectants, it leaves no harmful residuals. From a HVAC energy standpoint, the addition of a UVGI system does create additional air flow resistance and therefore the overall air flow rate of the system is maintained.


Retro-fitting a UVGI system in an existing building is relatively easy and not so expensive to install and operate. The first place to install an array of germicidal UV lamps is in front of the cooling coils inside of the air handlers. (Fig.5).

It is ironic that we pay so much attention to the amount of fresh air and recirculated air that we cautiously filter and that we then allow the air to go through a water dripping cooling coil fins huge surfaces contaminated with billions of living microorganisms.
A set of adequately placed UV lights shining on coil surfaces eliminates and prevents the formation of molds biofilm. Because of the long exposure time, very low UV power is required to keep the coil surfaces free of microorganisms’ growth. See before and after testing fig.6
As a rule of thumb, 50 watt per square meter of coil face is generally sufficient to keep a coil clean and eliminate the need for pressure jet washing with aggressive chemicals.
UVGI coil cleaning results in net energy savings as it keeps pressure drop to the minimum design value and always maintains the heat transfer rate.
From the building occupant’s health and wellbeing standpoint, the use UVGI has shown to be quite beneficial in a large epidemiological double-blind study published in the Lancet Medical Journal.5
UVGI was off for 12 weeks, then on for four weeks for three cycles totalling 48 weeks. Reliable data were available from 771 people. UVGI had a substantial effect in reducing reported work-related illnesses. In workers with symptoms in some, but not all weeks, UVGI resulted in a 20% overall reduction in all symptoms; a 40% reduction in respiratory symptoms; a 30% reduction in mucosal symptoms.
Fig.4 Combined UVGI + MERV 13 performance
Fig.3 MERV 13 Filter performance
Fig.5 Cooling coils contamination elimination
Fig.6 Cooling coils contamination: petri-dish before and after
30
FEATURE ARTICLES

In-duct air disinfection

After preventing the ubiquitous contamination by mold spores and other microorganisms when the fresh filtered air flows through a contaminated cooling coil, the next step consists in disinfecting the air from other bio-contaminants such as airborne viruses. This can also be accomplished by installing another type of UVGI device inside of the duct. Because the air is moving, the exposure time is limited and therefore more UV output power will be required to disinfect. To benefit from longer exposure time, it is preferable to install the UV lamps parallel to the air flow instead of perpendicular as depicted in fig.7.
However, unlike molds that require a very high UV dosage, some airborne viruses such as SARS-CoV2 are very susceptible to UV and will be easily deactivated with a much lower dose. A small UV dose of 12.2 joule per square meter i.e. 1.22 mJ/ cm2 is sufficient to deactivate 99% of the Covid19 virus.
The germicidal UV dose expressed in terms of joule per square meter is defined as the product of UV intensity in watt per square meter and exposure time in seconds. Given the size of a duct and its air flow rate, an array of multiple germicidal UV lamps are placed parallel to the air stream to maximize exposure time and deliver sufficient UV dosage to disinfect
Congratulations to Dr Normand Brais for being awarded the best presentation at the recent IHEA Perth national conference.
Fig.7 In-duct airstream disinfection
31
FEATURE ARTICLES
the air. A special calculation software is essential to properly predict the distribution of the UV dose across the duct and the resulting disinfection rates of the targeted microorganisms.
3 Roadblocks to the deployment of UV disinfection
It is remarkable that a technology as safe and effective as germicidal UV is not routinely in use in buildings where airborne infection is likely. Until the COVID‐19 pandemic, those might have included healthcare facilities, homeless shelters, nursing homes, and schools. The ongoing threat of pandemic have shown the necessity of air disinfection in a wider variety of public settings to reduce community transmission.
Roadblocks to deployment of germicidal UV disinfection are mainly :
1) Lack of awareness of the technology and misinformation about safety and efficacy
2) Shortage of technical experts to plan, appropriately size, install, commission, and maintain UV systems.

3) Invasion of new questionable almost magical devices, stimulated by the COVID‐19 crisis, is also becoming a nuisance to the legitimate use of time‐tested evidence‐based UV disinfection.
References
[1] Rothamer, D.A., et al. Strategies to minimize SARS-CoV-2 transmission in classroom settings: combined impacts of ventilation and mask effective filtration efficiency. Science and Technology for the Built Environment, 27:9, 1181-1203 (2021). https://www.tandfonline.com/doi/full/10.1080/23744731.2021. 1944665
[2] de Oliveira, P.M., et al. Evolution of spray and aerosol from respiratory releases: theoretical estimates for insight on viral transmission. Proceedings of the Royal Society A 477: 20200584 (2021). https://doi.org/10.1098/rspa.2020.0584
[3] P. Azimi and B. Stephens, “HVAC filtration for controlling infectious airborne disease transmission in indoor environments: Predicting risk reductions and operational costs,” 04 09 2013. https://www.ncbi.nlm.nih.gov/pmc/articles/PMC7127325
[4] Mphaphlele, Matsie et al. Institutional Tuberculosis Transmission. Controlled Trial of Upper Room Ultraviolet Air Disinfection: A Basis for New Dosing Guidelines. American J Respir Crit Care Med, 192(4), 477-4848 (2015). https://doi. org/10.1164/rccm.201501-0060OC
[5] Dick Menzies, Julia Popa, James A Hanley, Thomas Rand, Donald K Milton. Effect of ultraviolet germicidal lights installed in office ventilation systems on workers’ health and wellbeing: double-blind multiple crossover trial. The Lancet Medical Journal, 2003; 362: 1785-91 https://pubmed.ncbi.nlm.nih. gov/14654316/
32
P 1300 HIGGINS higgins.com.au FOR ALL YOUR PAINTING NEEDS OUR AREAS OF EXPERTISE INCLUDE: • General internal and external repainting Maintenance painting solutions National multi-site painting Colour and specification consultancy Specialised access Building Services Project Management ISO 9001 ISO 14001 ISO 45001 AS/NZS 4801 ST VINCENT’S PRIVATE HOSPITAL, TOOWOOMBA QLD Higgins Coatings is Australia’s premier commercial painting provider, with extensive experience in the healthcare industry. Australian family-owned and operated for over 70 years, we offer a flexible and localised service across our 19 branches, backed by a national network of experts.
Greater confidence in health

professionals and patient safety through features such as:
Integrated regulator Flow meter
Digital pressure Time remaining indicators.

Cost efficiency through effective use of cylinder contents and reduced equipment.

Suction device can be

connected directly to the cylinder
Visual and audible alerts





USING HEAT PUMPS FOR HEADING TOWARDS NET ZERO
Lasath Lecamwasam Director – Engineered Solutions for Building Sustainability. ESBS Pty Ltd
The Australian Capital Territory (ACT) Government in Canberra has set a target of achieving net zero carbon emissions by 2045. The reduction of gas consumption is an important requirement for this.
Abstract
Hospitals in Australia are estimated to consume 24PJ/y, the associated Greenhouse Gas Emissions being 4Mt CO₂-e/y.
Nearly 50% of this energy consumption is from Natural Gas, with space heating consuming about a third. Source: Baseline Energy Consumption and Greenhouse Energy Consumption in Commercial Buildings in Australia- COAG Nov 2012.
Due to climate change, there is an increasing awareness of the need to reduce gas consumption and where possible, to displace gas with electricity, sourced from sustainable sources.
This article describes an innovative and successful application of conventional low-temperature electric heat pumps that displaced gas consumption at two colleges in Canberra by 55% and 89%. The heat pumps were connected to the existing HVAC systems which consist of 4-pipe Air Handling Units (or Fan Coil Units), which could be typical for many HVAC systems used in different areas in Hospitals.
The technology is well-proven, and highly cost-effective, perhaps even cost negative when obsolete boilers and chillers are upgraded. With careful selection of equipment, plant optimisation, and the implementation of good controls for load management, it is even possible in some cases to achieve these savings with the need for costly upgrades to electricity substations, switchboards and submains.
The Australian Capital Territory (ACT) Government in Canberra has set a target of achieving net zero carbon emissions by 2045. The reduction of gas consumption is an important requirement for this.
This paper describes a novel hybrid heat pump solution, the first such application in Canberra and possibly in Australia, towards significantly reducing gas consumption (decarbonisation) at two schools in the ACT, and other buildings in New South Wales (NSW). The projects replaced life expired and obsolete R22 chillers with high efficiency reversible heat pumps that produce warm water in winter for pre-heating air in air distribution systems, using the existing cooling coils. During cold extremes, when the performance and output from heat pumps reduces drastically, high-efficiency gas-fired condensing type boilers provide supplementary heating through the existing heating coils.
Results indicate that such systems can reduce gas consumption by 80-90% in spaces that are served by 4-pipe
fan coil units, for a fraction of the cost of an all-electric retrofit, and with much less disruption including the requirement for power supply upgrades.
Keywords: Decarbonisation, Heat Pumps, Electrification, Heating Systems, Electric Retrofit.
1.0 Introduction
Winter temperatures in Canberra can drop down to -5⁰C. Older buildings, including schools have poor thermal insulation and high air leakage, which lead to high heating loads. Such buildings are typically heated by gas fired boilers within hydronic systems consisting of 2 or 4-pipe fan coil units, or steel panel radiators.
Typical schools that are served by 4-pipe fan coil units (or air handling units) have chillers that produce chilled water in summer for space cooling, and boilers that produce hot water for space heating in winter. In such systems, the chiller stays idle during winter. In this project, the concept of replacing obsolete R22 chillers with modern high efficiency, air to water reversible heat pumps was implemented. These machines produce chilled water in summer, and rather than idling in winter, they produce warm water, typically below 50⁰C, which is circulated through the cooling coils of the fan coil units in winter, which is somewhat counterintuitive. For extreme winter periods, which typically lasts less than 300 hrs per year for schools in Canberra, when the heat output and efficiency (expressed as coefficient of performance - COP) of heat pumps drop significantly, high efficiency, gas fired condensing type boilers were used to provide supplementary heating in extreme winter, using the heating coils in the fan coil units.
Replacement of existing gas-fired hydronic heating systems with fully electric options can be extremely expensive and disruptive, due to the necessity for upgrades to electrical sub-stations and building infrastructure including switchboards and cabling.
Due to the age of some of these buildings, any changes to electrical infrastructure is likely to trigger a number of technical and non-compliance issues such as the requirement for dual exits from switch rooms, the necessity for fire compartmentation and sealing of penetrations, seismic requirements for cable containment systems, the presence of asbestos, lead paint and other hazardous materials
35 FEATURE ARTICLES
FEATURE ARTICLES
which could be disturbed, and retrospective compliance with the current wiring rules (AS/NZS 3000) and the recently introduced switchboard standards (AS/NZS 61439).When making significant changes to HVAC systems, dealing with these associated issues across several schools can be very expensive and disruptive.
Therefore, an upgrade option which can replace life expired and/or obsolete equipment, including chillers that have R22 (which has been phased out due to its high ozone depletion potential), which also displaces significant amounts of gas with electricity for space heating, and without being very expensive to implement, can be very valuable to building owners or operators. In the pathway towards carbon neutrality, such an option could provide an interim solution to building owners facing budgetary constraints, for the next 10-20 years until cost effective technological advances in space heating systems and fuels such as Hydrogen which are favourable towards decarbonisation are established and proven.
Canberra has a total of around 90 public schools administered by the Australian Capital Territory (ACT) government, many of which have high space heating requirements served by gas fired hydronic heating systems. The total annual gas consumption from these schools is around 113TJ, which represents 5,800 tonnes of CO₂ emissions (1).
2.0 Project Description
Melba Copland and Hawker Colleges were constructed in the mid 1970’s. Melba College has a Gross Floor Area of approximately 10,000m² and Hawker College around 15,000m².
The key drivers for the heating system upgrades at these schools were concerns regarding the age and condition of the space heating boilers, which at Melba College was a 45-year-old 1.8MW unit which was a single point of failure, with spare parts being no longer readily available. Considering the severity of the Canberra winters, which could reach -5⁰C overnight, and the potential disruption through the loss of heating in a school, this was a major concern.
The main objectives were to improve reliability and resilience of the heating systems through replacing obsolete gas fired boilers. Other considerations included improving performance and occupant comfort, replacing obsolete R22 chillers and reducing overall maintenance requirements, including the removal of cooling towers-with the associated benefits of eliminating water treatment costs for the control of Legionella, and the associated water consumption costs. Working within budget constraints - initially set for simple boiler replacements - was also a key factor.
It must be noted that ideally, this project should have been accompanied by improvements to thermal insulation and draughtproofing, however due to reasons beyond our control it was decided by the client to defer such improvements for later, as part of a bigger programme towards improving the building fabric across older schools.
Engineered Solutions for Building Sustainability (ESBS) was appointed by the ACT Government to develop an engineered solution for the HVAC retrofit. Rather than merely replacing the boilers, which would have only reduced gas consumption for
space heating by around 15%, ESBS proposed an innovative solution that also upgraded the aging R22 chillers with reversible air-to-water heat pumps within a hybrid heating system, where the heat pumps integrated in tandem with gas fired boilers. The uniqueness of this system comes through using the existing cooling coils in the air handling units to supply space heating during winter, while still retaining the cooling function through the reversible heat pump for use in summer. During extreme winter, when the performance of heat pumps drops significantly, hot water is produced for supplementary heating by the high efficiency gas fired condensing type boilers through the existing heating coils in the fan coil units.
The project costs exceeded the original budgets allocated for a simple boiler upgrade. ESBS through a design options report, demonstrated the benefits of lower life cycle costs and the displacement of gas towards decarbonising before additional funding could be sourced for the heat pump upgrade, rather than a simple boiler replacement.
Collaboration between stakeholders was essential to the success of this project. Careful staging of the installation was required to minimise disruption to the functioning of the school. The installation at Melba College was somewhat disrupted by the ACT bushfires and COVID, however with careful planning and communication between all stakeholders, the impact on the operation of the schools was minimised. Constant communication of the key project goal of displacing gas was essential to optimise the new system to prioritise the operating of the heat pumps, especially during extremely cold weather, when these units struggle due to the low coefficient of performance, rather than use the gas fired boilers, which are unaffected by low ambient temperature.
3.0 Challenges Faced
The first challenge was to convince the client that additional expenditure was warranted for achieving long-term cost benefits. Rather than simply upgrade the boilers, the scope was extended to also replace the old and obsolete R22 chillers with heat pumps. Also, to control the new system efficiently, and for Measurement and Verification (M&V) it was considered necessary to upgrade the Building Management System (BMS).
Being the first project of this nature in the ACT (or perhaps in Australia), the project had its fair share of sceptics at various stages, including fellow consultants and contractors. ESBS had to explain the proposed engineered solution to these parties, backed up by relevant information including the performance of chilled water coils when used as a low temperature heating hot water coil at 45⁰C.To gain confidence in the outcome, in terms of heating capacity and gas reductions, a proprietary coil selection programme was used to predict the capacities of the existing cooling coils when performing as pre-heating coils in winter. Cooling coils are much deeper than heating coils, and the coil selection software confirmed that even with the lower flow and return temperatures of a heat pump (45⁰C flow, 40⁰C return), the capacity of the cooling coils, operating in heating mode, was sufficient to provide the space heating requirements, except for the extreme winter periods and during the optimised
36




FEATURE ARTICLES
morning warm up periods, when supplementary heat from the gas fired boilers would be required.
A study of historic weather data for Canberra was performed, which based on the peak heating loads, predicted a reduction in gas consumption of about 85%. The equivalent thermal energy would now be supplied through the heat pump, with the associated electricity consumption depending on the coefficient of performance.
For the new systems to deliver the predicted gas savings, this could not simply be ‘an install-and-forget’ type project. Careful testing, commissioning, monitoring, and optimisation was essential to ensure that the project goals of performance and reduction of gas consumption were delivered. Therefore, remote monitoring of the BMS was performed by ESBS during the 12-month defects liability period, with reporting that included any opportunities noted for BMS re-programming towards optimisation. This required remote access into the BMS to regularly monitor the system operation, the analysis of historical data on system operation, and working closely with the BMS contractor to review and optimise the control logic. Some of the fundamental issues identified during the earlier stages included the heat pump being disabled when the boilers were in operation to provide supplementary heating, boilers being incorrectly prioritised for heating over the heat pump, and over-sensitive and wasteful short cycling of the boilers in response to changes in heating demand.
The success of the projects was due to the commitment of all stakeholders during the monitoring period, which included the project managers and schools’ staff, and the BMS contractor’s good understanding of the project’s objective and commitment towards achieving it.
4.0 Project Outcomes
The project delivered the key objectives of enhancing performance, reliability and life cycle of the centralised thermal plant and significantly reducing gas consumption, within the budgets and time available. It demonstrated that through the application of well-engineered design solutions to retrofit obsolete HVAC equipment with a hybrid system consisting of electric heat pumps and high efficiency boilers, it is possible to reduce gas consumption for space heating by 85%, in areas that are served by 4- pipe fan coil units (or air handling
units). Such upgrades are very cost effective, even possibly cost-negative, when compared with like-for-like replacements of obsolete plant, because smaller boilers can be retrofitted to operate in tandem with the heat pumps in winter. The removal of cooling towers, with the associated costs for water treatment and water consumption was also a bonus.
Based on our experience from these projects, if systems are targeting the displacement of gas beyond 85%, such retrofits would become very expensive. This is because upgrades are then necessary to the electrical supply and distribution infrastructure including sub-stations, consumer mains, switchboards, sub-mains, and distribution boards. In older schools, such work is likely to trigger significant retrospective compliance issues for electrical and fire safety and expenditure for the safe removal of hazardous materials including asbestos and lead paint. Also, in older systems, air handling plant have been designed for heating hot water at 82⁰C/71⁰C from boilers and having lower heating hot water at 45⁰C/40⁰C from heat pumps alone, will significantly reduce the heating capacity. The upgrade of such air handling plant for operation with the lower flow and return temperatures from heat pumps alone would be very expensive. Results from other projects show that total electric upgrades can cost four to five times as much as what was achieved with electric/gas hybrid solutions at these two schools. Also, the additional electricity demand charges triggered by the increased winter peak heating demand, would lead to very expensive energy costs.
The results obtained from the first project (Melba Copland College) paved the way to investigate the feasibility of adopting similar systems for other projects of similar scope across other ACT Government sites.
At Melba Copland College, monitoring results demonstrated a 56% reduction in gas consumption, noting that only about 50% of the school’s floor area is serviced by 4- pipe fan coils, hence only these areas can benefit from the energy produced by the new heat pump, the other areas are served by equipment that only have heating coils. The reduction in annual gas consumption was:1,223,838 MJ.
At Hawker College, monitoring results demonstrated a 92% reduction in gas consumption. The reduction in annual gas consumption was 547,825 MJ.

 Figure 1 – Monthly gas consumption at Hawker College (before vs after project)
Figure 2 – Monthly electricity consumption at Hawker College (before vs after project)
Figure 1 – Monthly gas consumption at Hawker College (before vs after project)
Figure 2 – Monthly electricity consumption at Hawker College (before vs after project)
38
FEATURE ARTICLES
5.0 Lessons Learnt
Other lessons learnt from this project include the following:
a Additional space requirements for the installation of heat pumps, which have a much larger footprint in comparison to gas fired boilers. Also, air to water type heat pumps require un-impeded access to outside air, therefore should preferably be located outside. This may have several implications to the availability of space, aesthetic aspects, vandalism, and noise as described below.
b Heat pumps have relatively high noise emissions (when compared to gas fired boilers) that could disrupt the school and neighbouring properties. This is especially a factor during the early morning warm-up cycles, before 07:00 when lower boundary noise limits apply in many local authority requirements. Mitigation may require careful selection of equipment having special features including low ambient shrouds over refrigeration compressors, fan blades with owlet type profiles and variable frequency drives that ramp equipment gradually. At Hawker College, due to the proximity to neighbouring properties, an acoustic louvre was specified, and noise levels were measured before and after the project to verify that environmental impacts were within ACT Government requirements.

c The detailed specification of features in the BMS that include monitoring, trending, fault diagnostics (analytics) with the automatic generation of exception reports to assist with optimisation of the HVAC system to ensure that the heat pump operation is prioritised.
d Analysis of the maximum demand profiles from the heat pump is necessary at design stage to ensure that the existing power supply capacity is not exceeded. In one instance, months after successful operation of the heat pump, a school experienced a blackout. The cause was that the main switchboard had been upgraded, and in compliance with the utility provider’s requirements to ensure coordination of the circuit breaker with the utility supplier’s service protection device, the breaker trip setting had been lowered. Since the BMS retained a trend log of the energy sub-meter readings, it was easy to point out that the heat pump upgrade had not increased the power demand from the system demand, on the contrary it was lower than the maximum demand with the previous chiller.


It is important to note that after the retrofit of a heat pump, since the heat pump operates in winter, (unlike the previous chiller which was idling in winter), the electricity demand profile in winter will be higher. This will also
 Figure 3 – BMS monitoring of heat pump electricity use and boilers’ gas use on a monthly basis
Figure 4 – BMS monitoring of percentage gas offset from the installed system
Figure 5 – Plot showing heat pump COP established from BMS, against outdoor air temperature, up until the start of ACT COVID lockdown
Figure 6 – Original R22 water-cooled chiller
Figure 3 – BMS monitoring of heat pump electricity use and boilers’ gas use on a monthly basis
Figure 4 – BMS monitoring of percentage gas offset from the installed system
Figure 5 – Plot showing heat pump COP established from BMS, against outdoor air temperature, up until the start of ACT COVID lockdown
Figure 6 – Original R22 water-cooled chiller
39
FEATURE ARTICLES

increase the maximum demand charges for the winter months, which must be factored in any cost benefit analysis. Also, as more buildings are converted from gas heating to electric, it must be appreciated that power grid constraints will increase, and the need for augmentation of certain power supplies will be inevitable.
e It is important to manage client expectations to ensure that the central plant upgrade does not trigger complaints about pre-existing issues including faulty control sensors and other field items, air and water flow balancing issues, issues related to poor design and faulty control sensors and actuators in the field.
This can be managed by referring to pre-upgrade archived trends in the BMS that record any anomalies in performance including space temperatures, after-hours operation, and speeds on variable frequency drives. It is also important that heating hot water and chilled water flow rates are measured and recorded from key mainline balancing valves for comparing with post upgrade results, should any issues arise.
f The project cost for this upgrade was $0.99M. The results to date indicate that the reduction of gas consumption was 89%. Other benefits included improved occupant comfort, reliability, resilience, thermal efficiency and maintainability.
g Prices from tender returns indicated that if a 100% displacement of gas was targeted, i.e., a full electric option, then project cost would have been $2M, considering the necessary electrical infrastructure upgrades. We believe that the approach taken for this project, which was for a hybrid electric-gas solution, struck the right balance and the savings should be directed towards measures including better thermal insulation and the installation of measures such as solar PV or eutectic thermal storage, towards further reducing gas and electricity consumptions and maximum demand.
h The expected lifespan of the new heat pumps is expected to be 15-20 years. We believe that projects such as this will provide owners of poorly insulated buildings having gas fired heating, a relatively easy and highly cost-effective interim method towards carbon neutrality, by displacing significant amounts of gas. By the time the heat pumps need replacement, it is expected that heating fuels and technology would be less carbon intensive and the heat pump could relatively easily be upgraded, without significant changes to the other systems.
6.0 Conclusions
This project demonstrated that for existing buildings that have aging chillers, especially R22 - which has been phased out - their replacement with modern high efficiency reversible heat pumps provides a highly cost-effective method as a hybrid solution towards displacing gas for around 85% with electricity, for areas served by the heat pump. Considering that smaller boilers can be installed to supplement the heat pumps in winter, the financial costs may even be negative when compared with like for like replacements.
7.0 Measurement and Verification
Comprehensive Measurement and Verification (M&V) was carried out at Melba Copland and Hawker Colleges to assess the success of the project and compile lessons learnt for future projects. The heat pump-chillers were commissioned during Feb 2021 and immediately provided significant reductions in gas consumption from May 2921 as shown on the gas tracking portal on page 38.
Note: The plant was not operational in the months September and October due to the ACT COVID Pandemic lockdown.
New thermal and electrical metering has allowed the performance of the new systems to be analysed. Heating contribution from the heat pumps vs the consumption for gas boilers is shown by the BMS on a month-by-month basis, as in Figure 3.
The BMS is configured to track the gas offset in real time which allows any inefficient operations or issues to be identified quickly rather than waiting until the end of the gas billing cycle. The graph in Figure 4 shows that until July 2021, the system was tracking an 86% gas offset (based on thermal energy meters) which is in close agreement to the assessment based on gas bills.
The following graph shows that the heat pump chillers are maintaining good performance (COP), even at low ambient temperatures.
References
(1) ACT Government Annual Report 2020-2021 Education Directorate, 22nd December 2021, https://www.education.act.gov.au/data/ assets/pdf_file/0008/1908665/EDU-2020-21-Annual-Reportdownloadable-version.pdf
Biography
Lasath is a Chartered Professional Engineer with 40 years’ experience working in England, Scotland, New Zealand, and Australia, with a passion for sustainable and resilient design of new buildings and refurbishment of existing ones. Lasath’s experience across building services was gained through working on numerous projects that demand reliable operation, resilience, and sustainable operation. These include projects for the Royal Air Force, Australian Parliament House, High Court of Australia, Old Parliament House, National Library, National Archives, Australian Institute of Sports, Australian National Botanic Gardens, Air Traffic Control Towers, Hospitals, Fire and Police Stations, and Power stations in NZ and Australia. Lasath was the past president of the Canberra division of the Australian Institute of Refrigeration, Air Conditioning Heating (AIRAH) for five years. He is the founder and director at Engineered Solutions for Building Sustainability (ESBS) which he formed in 2015. The project behind the subject of the paper to be presented at the CIBSE Technical Symposium ‘Using Heat Pumps for heading Towards Net Zero’ was presented the AIRAH Award in the category of Best HVAC Retrofit or Upgrade in Feb 2022, in Sydney.
40

Redline is a non-structural internal reline coating for pressurised pipe systems and provides excellent resistance to high temperatures. Resin is blown into place using existing access points, meaning little disruption to users, operations, or the surrounding environment.




for copper, metal, iron and steel pipes or conduit transporting.

• �Hot & Cold Potable Water (including mains)

RECOMMENDED APPLICATIONS • �Suitable
• �Grey Water • �Compressed Air • �HVAC and other chemicals • �Fire suppression materials • �Steam • �Conduit piping • Size DN 15mm DN 200mm Pipes solutions@nuflow.net www.nuflow.net
PROACTIVE VS REACTIVE MAINTENANCE
Dr Mark Garvey Grosvenor
The Internet of Things (IoT) is radically changing the way we interact with the world around us. The ability to electronically manage and monitor physical objects, and optimise procedures and system functions puts data-driven decision making front and centre.
Withthe help of these tools, businesses and individuals can save time and enhance their quality of life.
In the context of building systems, IoT predictive maintenance is becoming mainstream. Using real-time information to forecast and fend off breakdowns can diminish downtime by a whopping 50%.
In the long term, being proactive and using data analytics is beneficial for you, your tenants, and your property.
Reactive Vs Proactive Vs Predictive
In the face of variables and circumstances beyond your control, there’s a best practice when it comes to asset management. To better understand the pros and cons of each approach, let’s break them down (pun intended).
Reactive Maintenance
This kind of upkeep reacts to equipment breakdowns or malfunction to return the asset to optimum operation after the incident.
Yes, it has lower upfront costs, but this type of maintenance costs more in the long run. Without weekly and monthly inspections, it requires less staff, but conversely –when problems do arise, you won’t have the relevant staff on hand to react. And when they do, you’ll probably have to pay overtime.
There’s also no need to spend time planning which means no scheduled downtime, however, when equipment fails, you’ll be dealing with downtime anyway. Without basic preventative maintenance, shorter equipment life expectancy is also a reality.

Reactive maintenance as a single strategy isn’t the way to go. Budgeting is unpredictable because when things do go wrong, you’ll need to fix it fast, often paying more for a fast turnaround. If equipment goes completely kaput, there’s no time to shop around; again, you’ll pay more.
Lastly, equipment that’s not thoroughly maintained will use more energy. Even slight faults cause electrical surges.
Proactive Maintenance
This approach to servicing is the middle ground. It aims to anticipate equipment issues before they happen by taking steps to stop them from occurring. This method requires scheduled regular maintenance and checks by a team of specialists, rather than reacting to breakdowns when they occur.
The schedule isn’t determined by data, but rather by a general maintenance plan.
Yes, checking assets in regular periods can increase lifespan and reduce downtime, but it still demands a significant investment of time, with the added inconvenience of prep and delegation.
While it’s a cut above a solely reactive approach, there are plenty of pitfalls. It works similarly to car maintenance: manufacturer-recommended service intervals based on
43 FEATURE ARTICLES
assumptions around part deterioration under standard driving conditions.
Compared to reactive maintenance, the main benefits are extending asset life which can help avoid downtime, as well as better workplace safety compliance. However, assets will still fail, and you’ll still waste time and resources. The risk of damage to machine components during unnecessary maintenance is also problematic.
Predictive Maintenance
This method is pretty much data-driven proactive maintenance, using recurring maintenance to stop failures, and in turn, downtime.
Predictive maintenance is smarter and more advanced than proactive maintenance because it’s based on cumulative data. For example, say historical data determines that machine Y’s bushings expire after an average of X days. A technician will then replace the bushings on machine Y every X days. This is done whether or not the machine specifically needs attention at that time.
This method also integrates HCAV, fire, electrical and other systems with IoT devices, so data is captured on all equipment and systems running your building.
Regular inspections protect people and property. As the opposite of a run-to-failure approach, predictive maintenance allows you to detect issues before they become a problem. You can then correct them and learn from your collective data so you don’t make the same mistakes twice.
This extends the life of your assets as they don’t depreciate as quickly. By predicting issues, you can lessen energy costs, and up efficiency. And because you’re lessening large-scale repairs, there aren’t as many breakdowns. Planned work happens in slow periods which means less disturbance to schedules and production.
Budgeting is better too – with tighter control, this approach gives you plenty of time to plan, source and buy parts, and line up labour. It also makes sure you comply with health and safety and grows customer service by providing efficient operations, on time, all the time.
The IoT Edge
The Internet of Things is transformative, from optimising operations to gathering better insights for data-driven decision making. The implications of IoT for building maintenance are titanic, with connected devices and sensors able to track control machines and key performance indicators (KPIs).
Building IoT to create a smart building accelerates data collection and yields in-depth analysis and pattern recognition leading to tech improvement and cost reductions. It can also increase customer experience and safety, and reduce risks. No matter the outcome, property owners, occupiers and managers agree ‘PropTech’ will change the world
Grosvenor Engineering Group (GEG) has created distinctive technology, data, software platforms and end-toend solutions in this space.

44
FEATURE ARTICLES
Prosperous Programs
Switching to prediction maintenance takes time. As you collect more info from your equipment, you’re left with precise, real-time data. This allows you to make the smartest maintenance decisions and start phasing out scheduled proactive maintenance. Eventually, your predictive model will prioritise maintenance where it’s most needed.
To successfully move from a reactive to a proactive approach, you need to understand the three areas of proactive facilities management.
1. Inventory and Maintenance Supplies
Creating an inventory of your current systems is vital in recognising the impact of facilities management. Know what assets, components and fixtures you have, as well as the condition of that equipment and your building as a whole. Take photographs to document it all.
2. Facilities Condition Assessment
For max efficiency, an ongoing condition assessment exposes inventory opportunities and weaknesses to help shape your proactive maintenance over the next 1-3 years. Create a breakdown of current equipment and

the expected repair costs for each. Factor in ongoing maintenance costs, and get estimates from qualified service vendors. Identify items beyond repair, renovation costs, and all real estate and warranty information.
3. Put a Plan in Place
Allocate resources for short and long-term maintenance. For the most comprehensive management, connect all your systems together through cloud-based tech and the Internet of Things.

Your Predictive Partner
GEG has applied data-driven maintenance (DDM) for many years via our Actionable Insights infrastructure – InsightsAI™ We find options for optimisation and can trial DDM on key areas like HVAC, fire and electrical, then scale to include plumbing, BMS, elevators, computer hardware and software, and internet services.
Extend the life of your assets, reduce the unforeseen costs of expensive breakdowns and improve building performance Speak with our talented Engineering Team to learn how we can help you proactively manage your operational assets.
45





















What are the Advantages of Applying Adiabatic Humidification in a Hospital?
Article supplied by Carel Australia
The “Generale M.G. Vannini Figlie di San Camillo” hospital in Rome has a level 1 emergency department and is part of the regional healthcare network. The hospital needed to install humidifiers in the fifteen existing air handling units (AHUs), so as to ensure the humidity level needed in the spaces served by the units.
Tenof the AHUs were already equipped with isothermal humidifiers that delivered a total of 272 kg of steam/ hour for a power consumption of 204 kWh. When taking all factors into account, approximately 750 Wh of energy is needed to generate 1 kg of steam at atmospheric pressure, energy that can come from electricity or other sources.
The work was aimed at making humidity management more energy efficient, while conforming with the hygiene requirements and without modifying the structure or components of the existing air handling units.
BEFORE THE WORK: ISOTHERMAL HUMIDIFIERS
Isothermal technology with immersed electrodes works by heating water (Joule effect) until it boils, producing steam. The quantity of steam produced is proportional to the electric current, which is in turn proportional to the water level. This electric current is measured by a current transformer: by varying the level of water using a fill solenoid valve and a drain pump, the current, and consequently steam production, can be modulated. For immersed electrode humidifiers, which do not use water from a reverse-osmosis system, the water level decreases as a result of evaporation and therefore needs to be refilled. As the steam does not carry mineral salts, the salt concentration of the water gradually increases, until becoming potentially corrosive; the sophisticated control software keeps the water concentration at the optimal value, ensuring the best compromise between water and energy savings, and humidifier operating life. Over time, scale builds up on the cylinder, however this can be easily replaced or cleaned.
ADIABATIC SYSTEMS TO INCREASE ENERGY EFFICIENCY
We therefore opted to install adiabatic systems, which perfectly fit the existing air handling units without modifications and therefore extra costs. In particular, the proposed solution involved using adiabatic humidifiers on a large scale. The design proposal was completed by the use of isothermal humidifiers only where these where needed in order to meet the project requirements.
Adiabatic humidifiers bring about direct evaporation of water into the air without requiring an external energy supply; the heat required for vaporisation is provided by the air, which is thus cooled. These units create a large contact surface between air and water in the liquid state causing the droplets to spontaneously evaporate.
This principle is used by atomising or spray humidifiers, which generate very fine droplets of water, measuring in the millionths of a metre in diameter. These droplets have a very large surface area, leading to rapid evaporation of the water. 1 kg of water atomised into 10 micrometre diameter droplets has a surface area of 600 square metres!
The main advantages of spray (adiabatic) humidifiers are:

• very low power consumption: high pressure systems require less than 4 W per kg/h of capacity, against the 750 W of steam humidifiers
• high capacity: capacity can range from a few kg/h to thousands of kg/h
• very low maintenance, especially when supplied with demineralised water
47 FEATURE ARTICLES
FEATURE ARTICLES
In the past, adiabatic humidifiers were not used in applications with high hygiene requirements, mainly because they recirculate water. Nowadays, however, the most advanced adiabatic humidifiers have a high absorption efficiency (the ratio between water absorbed by the air and water sprayed), hence they no longer recirculate the water. Furthermore, they avoid stagnation through periodic washing and emptying cycles, and use demineralised water and bacteriostatic materials.
Adiabatic humidifiers are now increasingly used for energy saving applications: direct or indirect evaporative cooling in the air handling unit or directly in the room, with very low power consumption while providing substantial cooling of the air using plain and simple water.
CAREL ADIABATIC TECHNOLOGIES
CAREL proposed the following solutions:
• CAREL humiFog Multizone Touch
It’s is an atomizing adiabatic humidifier which uses the pressurized energy given by a pump and the nozzles mounted on the edge of a frame (rack) to atomize demineralized water into micrometric drops in the air treatment duct or in the environment to humidify. Its hygiene certificate, in accordance with standard VDI6022 (the most up to date technical standard on the subject of hygienicity of HVAC equipment), allows installation in hospitals and clean rooms.
Thanks to the technology used, humiFog proves to be a highly efficient and accurate product. The efficiency is given by the high pressure: the volumetric piston pump allows it to reach a pressure of 70 bar, which, together with the special nozzles, atomize the water in droplets of a diameter of approximately 15 µm. The accuracy is given by a series of factors:
• the inverter, which acts on the rotation speed of the pump and on its modulation and therefore follows the request with accuracy up to 1%
• the solenoid valves on the edge of the rack intercept the flow rate provided by dividing it into steps in order to meet the instantaneous demand
• the CAREL electronic controller (c.pCO) ensures advanced and precise control of system operation and parameters. humiFog Multizone Touch is available in the following sizes: 150, 300, 500, 800, 1200 l/h. The distribution system (rack) is designed on the specifications of the customer, it will have ad hoc dimensions and capacity depending on the characteristics of the project and on the air treatment unit.
• humiSonic Ventilation
humiSonic makes adiabatic humidification available to smaller ducting systems, offering a high energy efficiency alternative to steam humidification. Energy consumption per kg of evaporated water is in fact 90% lower than with steam. Installed directly in the air flow, humiSonic can atomise water into very small droplets (5 µm on average), which are instantly absorbed.
The new generation humiSonic embodies all the attention that CAREL has always paid to the hygiene of its humidification solutions. All components in contact with the water are made from stainless steel, and not water is left to stagnate in the main body at the end of the humidification cycle. In addition, the electronic controller manages periodical washing cycles when the system is not running.
These hygiene features, together with the very high precision that humiSonic can achieve (±1% around the relative humidity set point), make it an ideal solution even for more critical and delicate applications, such as cleanrooms.
This humidifier comprises two elements that make it a powerful and complete solution: the main body (containing the piezoelectric transducers) and the electrical power supply and control panel.
optiMist
optimist is a humidifier and adiabatic evaporative cooler that, by atomizing water into small droplets, allows the latter to evaporate spontaneously, subtracting heat from the humidified air, which is cooled at the same time. The system consists of a cabinet, inside which there is a flap valve pump, with pressures up to 15 bar, and an atomized water distribution rack, to be installed inside the air treatment unit.
The control system is managed by the pCO, which combines the action of the inverter (that regulates the speed and therefore the flow of the pump) and that of the two solenoid valves, which activate only the nozzles that are necessary, allowing the system to operate always at optimum pressure in a wide flow range. The two solenoid valves (placed inside the cabinet) divide the distribution into two independent steps, which can be simultaneously present on the same rack (acting one after the other sequentially) forming two steps of continuous modulation, or they can be separated in two different distribution systems, each with a single step, supplying two different areas: this is the typical case of the application of humidification + direct adiabatic cooling in the input duct and indirect adiabatic cooling in the output duct, with heat exchanger between the two air treatment units.
The optiMist cabinet is available in the following capacities: 50, 100, 200, 400, 800 e 1000 l/h. The distribution system can be selected from a large list of available codes, depending on the size of the duct and the atomization required. optiMist can be used with demineralized water, but also with mains water, as long as the unit is cleaned more frequently.
THE RESULTS
The three models described were installed on nine of the air handling units included in the work, for a total guaranteed capacity of 524 l/h and maximum power consumption of approximately 8 kW; making a direct comparison against the expected energy consumption in isothermal mode,
48
the ratio is approximately 49 times higher, as shown in the graph below.
This evidence highlights how an improvement in energy efficiency is not only a solution that meets the needs of energy managers and designers of healthcare structures (and indeed any type of structure), as well as of customers who care about their bottom line; indeed, these units guarantee a very fast payback on the investment (also considering the limited requirements in terms of electrical components, such as panels and wiring).
To ensure lower maintenance, this type of humidifier has been combined with several reverse-osmosis systems. Reverse osmosis is a technique in which the water being purified is pumped through a semi-permeable membrane with pores less than 0.001 μm in diameter: most of the dissolved ions are filtered out by the membrane, thus producing essentially pure water. The removal of minerals, measured as a percentage of the original content, varies from 95% to 99% and even higher. Automatic operation and limited running costs extend the use of this technology, with undisputed advantages. The reverse osmosis demineralisation, together with the UV lamp disinfection system, guarantees the highest level of feedwater hygiene. Specifically, demineralised water avoids fouling of the nozzles, the build-up of mineral salts in air handling units and the introduction of mineral dust into the humidified environments.
Maintenance costs are reduced, and the hygiene of ventilation systems is improved, as the RO water has been purified of all bacteria and pollutants.

Furthermore, in the case of ultrasonic humidifiers, elasticity of the transducers installed at the bottom of the tanks and essential for operation of these appliances is not affected by fouling.
In conclusion, the results achieved were:
• efficiency of the overall humidity distribution system, in both technological and energy terms,

• achievement of the goal of hygiene
• lower maintenance costs
• upfront costs limited to the humidifiers only, without having to modify the AHUs already installed
• flexibility of the proposed solutions.
49 FEATURE ARTICLES
Door systems for mental health that improve safety and reduce risk www.kingswaygroupau.com Door systems for mental health that improve safety and reduce risk www.kingswaygroupau.com Door systems for mental health that improve safety and reduce risk www.kingswaygroupau.com 1800 325 175 www.kingswaygroupau.com 144/146 Russell Street Emu Plains NSW 2750

 Serious Air Purifiers, Seriously Clean Air.TM
Serious Air Purifiers, Seriously Clean Air.TM



THE ANATOMY OF A DECARBONISED MEDICAL FACILITY
 By Matthew Doley
Market Development Manager – Smart Buildings, Electrification, ABB Australia
By Matthew Doley
Market Development Manager – Smart Buildings, Electrification, ABB Australia
Digital technologies and energy management solutions that sense, monitor, control and optimise the built environment while it interacts with individuals are at the core of decarbonising hospitals and healthcare facilities. And they play an important role in reducing energy consumption, increasing energy efficiency and the adoption of renewables.
There are five key steps to achieving carbon neutral hospitals and healthcare facilities and buildings:
1. The first step is to deploy digital solutions and energy management such as monitoring, control and optimisation, which is at the core of decarbonising buildings.
2. Next is to increase energy efficiency by utilising building management systems and installing new, highly efficient motors and drives for example.
3. Expanding electrification is also important. For example, heat-pumps and having an electric vehicle (EV) charging infrastructure.
4. The installation of distributed renewable energy solutions should also feature in a low-carbon strategy – from photovoltaic technology and wind turbines, through to battery energy storage systems and thermal energy storage.
5. The final step is to procure renewable energy from the grid and offset any remaining emissions.
The technology blueprint
It is important to point out here that achieving carbon neutrality in a new building is easier to achieve ‘by design’ than in older building stock that requires retrofitting. In the absence of a ‘one size fits all’ blueprint, our customers understand that their projects are unique, and feature a combination of existing systems and equipment built over time.
This is why open-source technology and the interoperability between systems is so important. In order to meet Net Zero building targets, we must be able to retrofit a large percentage of existing buildings. And solutions need to be easy to install, with impact and return on investment clearly defined.
Whilst not all technology blueprints for a smart, carbon neutral site are exactly the same, a typical customer smart building will use interconnected technologies to improve comfort and performance across energy management, water use, air conditioning, access, automation, lighting, remote monitoring, and communication networks.
Thanks to ABB’s solution areas within the ABB Ability™ Building Ecosystem, for example, hospital and building operators and facility managers can have digital control of all these elements, and smart buildings will capture the transformative opportunities to become more environmentally friendly – from substantially contributing towards carbon reduction targets through efficiency gains in heating and cooling equipment and in the building itself.
The ABB digital solutions enable constant surveillance and optimum control of energy production, consumption and storage. Largely autonomous, this learning system calculates the optimum energy flow based on predictive data and compensates for deviations in real time. In a carbon neutral site, these technologies are combined for a holistic approach that can be easily scaled according to the requirements of the building.
52 FEATURE ARTICLES
FEATURE ARTICLES
The digitalisation of buildings through connected technologies and building automation also has a key role to play in helping to manage grid resilience and reliability as well as reducing energy costs and increasing energy efficiency. Moreover, it is an important step towards the energy transition. It enables the building to provide valueadding services towards the modern energy grid and thus supports the shift from “consumer” to “prosumer” – facilitating concepts such as virtual power plants and maximising the value of distributed energy resources (e.g. photovoltaic, batteries) on a broader scale.
In short, the typical solution scope for a carbon neutral building project includes distributed energy resources – such as on-site photo voltaic technology, EV-chargers, energy storage, motors & drives, power supply & protection – as well as digital solutions for energy management including monitoring, control and multi-purpose optimisation. Also, building automation & heating, ventilation and air-conditioning (HVAC) controls such as digital integration platforms, building automation & control, HVAC control & optimisation, space management and wellness & productivity.
Call Cameron direct on 0416176166 cameron@aciaelectrical.com.au
Specialist in AS 3003 2018, Body and Cardiac Protect. Designing, installing, commissioning and reporting to the standard.
Installing electrical services up to 2000 amps, from the design concept to the commissioning of switch board, generators and transfer switches.

Installation of power/ lighting and communications for all parts of the hospital, with detail refence to AS 3000 and AS 3003.
ACIA Electrical Services can provide Energy monitoring and engineered reports to determine condition of the electrical systems. We use the FLUKE 434 Series 11 monitor to capture the information.
Specialising in medical theatres and imaging departments, including supplying X ray warning signs .

ACIA Electrical Services provides UPS’s, voltage stabilizers, power factor correction units and power filters, to any installation which requires protection.
Over 20 years of working in the medical industry

53
Introducing Zip HydroTap UltraCare

PROVEN TO DELIVER 99.9% REDUCTION IN LEGIONELLA*

Zip HydroTap UltraCare uses a multi-barrier system for the prevention and control of Legionella and other waterborne bacteria.
Designed for health and aged care customer needs, Zip HydroTap UltraCare is powered by G5 technology and is available with Touch-Free Wave, a 100% contactless solution to instantly dispense pure-tasting drinking water with a simple wave of a hand.
It’s not just water, it’s water at its best. Visit zipwater.com
*ALS Pty Ltd Testing of the Zip HydroTap UltraCare system efficacy tests
EXPERIENCE WATER AT ITS BEST PURE-TASTING | INSTANT | BOILING | CHILLED
AIR PURIFIERS IN HOSPITAL AND HEALTHCARE SETTINGS
Nicholas Kraus InovaAir Australia
Air purifiers utilising HEPA filters (High-Efficiency Particulate Air) have become commonplace in hospitals and healthcare facilities with the primary aim of reducing airborne transmission of SARS-coV-2. The benefits of portable air filtration in hospitals include lowering room-to-room transmission and making areas safer for staff and patients.
Withair purifiers gaining popularity in healthcare settings it’s important to take a closer look at filtration efficiency to ensure these devices function as intended with the highest possible capture rate for aerosols containing SARS-coV-2 or other pathogens.


Filtration Efficiency
At its most basic level, an air purifier is only going to perform as well as the filters inside. When you are dealing with filtering viruses from the air, you need to select an air purifier with a medical-grade HEPA filter. Medical-grade refers to top-tier H13 or H14 efficiency-rated filters that will capture a minimum of 99.95-99.99% of particles @ 0.3 microns (PM 0.3) or larger. These are the same filters relied upon in infection control isolation rooms and operating theatres.
HEPA Filter Types
HEPA air purifiers commonly use either a synthetic pleated HEPA type filter or medical-grade, EN1822-rated HEPA paper.
HEPA ‘type’, commonly synthetic filters are made from polypropylene media with an electrostatic charge, the charge improves filter efficiency so the filter media will let through fewer particles. Synthetic filter media is used for 2 reasons; it’s lower cost to manufacture and it creates less pressure drop, so the fan in the air purifier can be smaller.
The electrostatic charge on the filter media essentially magnetises the filter material to hold and capture more dust and particles, however, the caveat is the charge dissipates over time and causes the efficiency to reduce. In tests we have performed on synthetic filters we have seen a reduction
from 99.95%, down to less than 75% during six months of use.
Synthetic filters usually cannot be certified as some ultrafine particles will penetrate the filter and therefore fail the stringent EN1822 efficiency tests. By contrast, HEPA paper, also known as glass paper, maintains the same very high efficiency for the life of the filter.
55 FEATURE ARTICLES
Filter Class (EN 1822)
E11
E12
H13
FEATURE ARTICLES
Filter Class (ISO 29463)
Overall Efficiency (%)
ISO 15 E ≥ 95
ISO 25 E ≥ 99.5
ISO 35 H ≥ 99.95
H14 ISO 45 H ≥ 99.995
U15 ISO 55 U ≥ 99.9995
U16 ISO 65 U ≥ 99.99995
U17 ISO 75 U ≥ 99.999995
HEPA Air Purifier Selection Criteria
A common misconception in healthcare procurement is that all HEPA air purifiers are similar, the main assessment criteria for purchasing are based on system price, availability and how much are ongoing filter replacement costs.
Air purifiers available from electrical retailers are typically sold to consumers for their homes for dust and allergen removal and are not engineered for demanding healthcare environments.
Unfortunately, as mentioned above the term “HEPA” is used by all manufacturers, it’s up to the purchaser to determine what standards the manufacturer has engineered the filter to comply with.
Below are the 8 different classes defined under EN1822 and their filtration efficiency. Efficiency is determined by removal rates of the most penetrating particle size (MPPS).
EN1822 is a more stringent standard that tests the efficiency of the actual filter. A filter will either pass or fail the test
Most viruses are estimated to be 0.1-0.125 microns in size; H13/H14 HEPA is effective in filtering approx. 95% or greater of particles @ 0.1 microns. Airborne viruses are usually spread when the virus is aerosolised in fine droplets in the air and these are typically 0.5 microns in size and larger.
Clean Air Delivery Rate (CADR)
Clean Air Delivery Rate, also known as ‘CADR’, is a home air purifier standard developed by the Association of Home Appliance Manufacturers in the US.
CADR measures reductions in certain particle sizes and smoke in a test chamber over 10 minutes. It was not intended to be used for applications involving SARS-coV-2 reduction of aerosols.
As with other commercial air filtration applications, filter test classifications including ISO and EN1822 provide a more reliable means of guaranteeing filter efficiency and knowing what the actual efficiency of the filter is.
Synthetic filters mentioned above provide good performance in CADR tests because the filter is only being tested for minutes, long-term performance can be significantly reduced and the end user will not be aware of this unless they are using a laser particle counter to measure the filter efficiency.
Key Points:
• The majority of air purifiers are not medical-grade filters (H13/H14 efficiency) and contain synthetic filters with lower E11 - E12 efficiencies.
• Buyer Beware: synthetic HEPA-type filters using materials like polypropylene do not maintain the stated efficiency for the life of the filter, HEPA paper is the only material guaranteed to maintain efficiency for the life of the filter. Synthetic filters use an electrostatic charge on the filter material which assists efficiency but over time the charge is lost and so is the efficiency.
• Bigger is better: the larger the size of the filter surface area (usually measured in m2) increases the efficiency of the filter due to a larger contact area. When comparing air purifiers look for the largest filter in size.
• The Clean Air Delivery Rate (CADR) advertised by many mass-produced air purifiers is not indicative of overall filtration efficiency.
• Air purifiers that direct airflow in all directions tends to recirculate their air at lower speeds making them less effective.
56
SUSTAINABILITY HOSPITAL ESTATES STRATEGY IN THE AGE OF THE CLIMATE EMERGENCY
HOSPITAL ESTATES STRATEGY – DO NOTHING, RETROFIT, OR REBUILD?
WHOLE LIFE CARBON CALCULATIONS’ ‘INTEGRAL PART’ / STUDY FOCUSED ON WHOLE LIFE CARBON AND COST
Tim den Dekker, Dr Joe Jack Williams, Ian Taylor
There has been growing focus on the Climate Emergency that our globe is facing, with converging pressures creating what has been described as a ‘perfect storm’. Whilst some of this might seem removed from us “Down Under”, our healthcare engineering colleagues in Europe are dealing with very real pressures resulting from the conflict in Ukraine, putting unprecedented pressures on energy supplies, together with the growing humanitarian crisis. At the same time, we and other parts of the world, are dealing with other climate related emergencies including floods and fires, whilst healthcare systems are struggling with the burgeoning cost of energy supply. As facility and site managers, all of us are aware of the intense energy consumption associated with delivering healthcare services, so there are many considerations to be cognisant of. In this article we get to explore some of the initiatives being considered in the UK, and it is worthy of our attention to learn from those who have shared this with us.
The
UK construction sector is gearing up to make Whole Life Carbon (WLC) calculations integral to design decisions and standard reporting, to help meet the UK, and the NHS’s emission reduction targets. Tim den Dekker, an associate architect at Feilden Clegg Bradley Studios, and his colleagues, associate and researcher, Dr Joe Jack Williams, and managing partner, Ian Taylor, discuss the outputs from a detailed study by the practice of a 35-year-old London NHS hospital building to review the range of considerations faced by an NHS Trust and its Estates department in the context of WLC and cost. They say ‘the results demonstrate the value of such calculations’.
The strategic direction set out in Delivering a ‘Net Zero’ National Health Service1 requires hospital Trusts to decide how to reduce carbon emissions. A quick calculation using the figures in this document suggests that operational and embodied carbon relating to buildings makes up approximately 1% of the UK’s carbon footprint. NHS Trust Estates teams therefore have an important role in reducing UK emissions. A high proportion of NHS building stock is old and dilapidated. Shedding light on important estate management decisions that NHS Trusts need to make to save carbon and meet changing demand patterns and clinical standards, our study found that the bulk of the emissions reductions to meet UK and NHS targets will need to come from embodied carbon. This finding is consistent with the UKGBC Net Zero Whole Life Carbon Roadmap’s call for the mandatory embodied carbon limits, which could be delivered by Part Z,2 a ready-made proposed amendment to the Building Regulations.
Measuring return on invested capital
Emissions reductions must be considered a part of measuring return on invested capital to evaluate different development options. We found that a retrofit consisting of envelope and
57 INTERNATIONAL STORIES
INTERNATIONAL STORIES
LCA modules included in the analysis
We have included LCA modules A1-A5 (‘Cradle to Completion’), B2 (maintenance), B3 (repairs), B4 (refurbishment), and B5 (replacement). We combined LCA modules B2 (maintenance) and B3 (repairs) as they are very much interrelated.
systems upgrades to reduce heating/cooling demand and improve efficiency gives the highest carbon savings per £ spent. In contrast, a new-build – say, to better provide for high-acuity uses, improve space standards, and future flexibility, in addition to having better envelope performance and heating/cooling systems – significantly increases upfront embodied carbon, with little impact on WLC, and is therefore poor value from the perspective of carbon saved.
On the financial side, higher revenues are a likely result of building improvements leading to better well-being and clinical outcomes that should result in shorter hospital stays and higher patient throughput. These improvements are expected from both new-builds and envelope and systems retrofits, although the analysis to support this hypothesis was outside the scope of our study. What we did find, however, is that savings in heating costs cannot be relied on to provide a return on any investment to improve building fabric and/or systems.
Based on our findings, we propose that as a rule of thumb, new-build should be reserved for high acuity functions that have unique requirements unable to be met by existing building stock. These requirements, for say theatres, imaging, and intensive care, would include deep service zones, longer

LCA modules excluded from the analysis
Because the relative impacts of LCA modules B1 (Use) and B7 (Operational water use) are negligible, we have excluded them from our analysis. Also, we excluded endof-life emissions (modules C1-C4) for three reasons: (1) it is a small part of overall WLC; (2) its level is highly uncertain being very far in the future, and (3) its emission is not expected to change the relative calculations for the options introduced in the next section.
58
FCBStudios’ Stirling Prize-shortlisted retrofit of the Manchester School of Art included envelope, systems, and space standard upgrades (much like Retrofit* and RetrofitExtend* in this study) Image credit: www.manchester-architecturalphotographer.co.uk 10,000,000 20,000,000 30,000,000 40,000,000 50,000,000 60,000,000 70,000,000 80,000,000 90,000,000 2022 2027 2032 2037 2042 2047 2052 2057 2062 2067 2072 2077 Cumulative Emissions NewbuildFlex* A1-A5 Upfront Embodied B2+B3 Maintenance+Repair (Embodied) B4 Replacement (Embodied) B5 Refurbishment (Embodied) B6 Operational 42% 8% 21% 2% 27% Figure 1: Whole Life Carbon (WLC) emissions profile for a new-build hospital with highly efficient building fabric and heating / air-handling systems.
spans, high load capacities, and low vibration tolerances. All other accommodation should as far as possible be provided in existing buildings, retrofitted as necessary. We recommend that this proposal is incorporated as strategic guidance in the next version of the Delivering a ‘Net Zero’ National Health Service document.
Factors beyond the study’s scope
Other factors that should feature in decision-making, but were beyond the scope of this study, include the impact on clinical activities caused by disruption from construction (refurbishment or new-build) and decants, and by the retention of building fabric and potentially suboptimal space standards, levels of servicing, and adjacencies. Furthermore, the carbon reduction measures of this study should be considered alongside the many other significant opportunities identified in Delivering a ‘Net Zero’ National Health Service, such as preventative medicine, a shift to low carbon asthma inhalers, and zero emission vehicles.
The outcomes from our study are constrained by parameter assumptions. We have tested the sensitivity to varying key assumptions, and believe that the metrics shown give a good relative and directional representation for the strategic options considered. Although more work is needed to improve confidence in the absolute values of the metrics, we expect this will not significantly change their relative values.
Emissions targets
The UK’s emissions reduction targets are a bold 78% reduction over 1990 levels by 20353 (i.e. within the next 13 years). This level of reduction is needed to keep global warming below 1.5 °C-2 °C, the consensus for minimising the likelihood of key global systems reaching tipping points.4 The
NHS’s emissions reduction targets are set out in Delivering a ‘Net Zero’ National Health Service. These are marginally more ambitious than the UK targets, at an 80% reduction over 1990 levels by 2028 to 2039 (i.e., within the next 6 to 17 years), with the date depending on the scope of emissions measured.5 The reductions and timescales are very ambitious, and will require a step change from how NHS estates are currently managed and (re)developed.
The importance of upfront embodied carbon
The first reason to prioritise reducing upfront embodied carbon emissions on new construction is that time is quickly running out. NHS emission reduction targets must be met in 6-17 years, which is a small fraction of a building’s theoretical lifetime of 60 years. The second reason is that embodied carbon forms a substantial share of emissions from new construction or major refurbishments. Our study shows that for a new hospital with a high-performance fabric and highperformance heating and air-handling systems (ASHPs and MVHR), and assuming future decarbonisation of electricity, operational carbon (Module B6) can be as low as little more than a quarter, and embodied carbon almost as high as three quarters of lifetime carbon emissions, measured over 60 years. Furthermore, upfront embodied carbon (LCA modules A1-A5) can be more than 40% of lifetime carbon emissions. This is illustrated in Figure 1.
The approximately 75/25 split between embodied carbon (construction, repairs, and replacement) and operational carbon (heating, cooling, lighting, appliances) differs from the current rule of thumb assumption of 50/50 for all buildings. This difference arises from factors such as the high proportion of high embodied carbon MEP systems in the fabric of hospitals, and the assumed decarbonisation of electricity into the future.


59 INTERNATIONAL STORIES
Figure 2: Comparison of projected 60-year cumulative WLC emissions50,000,000 100,000,000 150,000,000 200,000,000 250,000,000 2022 2032 2042 2052 2062 2072 Cumulative Carbon Emissions Cumulative carbon emissions DoNothing* (Opt 1) Retrofit* (Opt 2) RetrofitExtend* (Opt 3) Newbuild* (Opt 4) NewbuildFlex* (Opt 5) 2035 UK GHG emissions target: 78% reduction from 1990 levels








Redevelopment strategy options
Our study considered the impact of different redevelopment strategies for a 30,000 m2 hospital building constructed in the mid-1980s, built to the standard of the then-prevailing building regulations and clinical space standards (poor compared with current standards).
These strategies are represented by five different options.
Option 1 (DoNothing*) – Do nothing / continue ‘as is’; no building upgrades, apart from backlog maintenance.
Option 2 (Retrofit*) – Retrofit; upgrade the building envelope (overclad) and heating systems to current Part L standards, as well as undertaking remaining backlog maintenance.
Option 3 (RetrofitExtend*) – Retrofit + extend; Like Option 2, but extend the existing building (at the upper limit of PassivHaus standards for the new build) to enable internal reconfiguration to meet current healthcare space standards.
Option 4 (Newbuild*) – Demolish and rebuild to the upper limit of PassivHaus and current healthcare space standards
Option 5 (NewbuildFlex*) – New-build + flex; Like Option 4, but with additional ‘flex’ in plan space and floor-to-floor heights to facilitate ease of future adaptation
To help with readability we have used the terms DoNothing*, Retrofit*, RetrofitExtend*, Newbuild*, and NewbuildFlex* in the text to refer to these five options.
We followed the methodology set out in the RICS Professional Statement, Whole life carbon assessment for the built environment, and measured the two key components of WLC:
Figure 3: Projected 60-year cumulative carbon emissions by WLC component module for each strategic option (all shown at the same scale).
61 INTERNATIONAL STORIES
50,000,000 100,000,000 150,000,000 200,000,000 250,000,000 2022 2027 2032 2037 2042 2047 2052 2057 2062 2067 2072 2077 50,000,000 100,000,000 150,000,000 200,000,000 250,000,000 2022 2027 2032 2037 2042 2047 2052 2057 2062 2067 2072 2077 50,000,000 100,000,000 150,000,000 200,000,000 250,000,000 2022 2027 2032 2037 2042 2047 2052 2057 2062 2067 2072 2077 50,000,000 100,000,000 150,000,000 200,000,000 250,000,000 2022 2027 2032 2037 2042 2047 2052 2057 2062 2067 2072 2077 50,000,000 100,000,000 150,000,000 200,000,000 250,000,000 2022 2027 2032 2037 2042 2047 2052 2057 2062 2067 2072 2077
• Embodied carbon emissions from new construction and fabric maintenance, repair, renewal, and refurbishment (modules A1-A5 and B2-B5), and
• Operational carbon emissions from heating/cooling (module B6).
Aside from physical estate redevelopment there are other important ways of reducing building whole life carbon emissions from NHS buildings, such as reducing space use through technology-enabled virtual care and intensive timetabling, better building systems programming, and simplified building operation to help users reduce energy use. These topics will be addressed in future studies.
Our findings
Our study found that the greatest reductions in short- and long-term emissions come from Retrofit*: making the walls, windows, and roofs better at keeping heat in or out (‘envelope upgrades’), and changing heating systems from gas-fired to electric heat pumps (‘system upgrades’).
Although DoNothing* and Retrofit* represent the lowest cumulative GHG emissions by 2035 (the UK target date for 78% GHG emission reduction), Retrofit* represents the preferred approach to meet both short term savings over RetrofitExtend*, Newbuild* and NewbuildFlex* (by avoiding
new-build) and long term savings over DoNothing* (through greater fabric efficiency).
Embodied carbon
The embodied carbon cost of fabric and systems retrofit (Retrofit*) is recouped by the operational carbon savings over business as usual (DoNothing*) within approximately five years – the point where the cumulative carbon emissions lines for the two options cross.
The relative values of different WLC modules over time are best compared in the cumulative emissions charts for the different strategic options, as shown in Figure 3.
Option 1 – DoNothing*: No building upgrades, apart from backlog maintenance (showing up in B3).
• B6 dominates
Option 2 – Retrofit*: Upgrade the building envelope (overclad) and heating systems to current Part L standards, as well as undertaking the remaining backlog maintenance.
• Increase in A1-A5 for the retrofit is more than compensated for by the reduction in B6.
Option 3 – ‘Retrofit+’: Like option 2 Retrofit*, but extend the existing building (at the upper limit of PassivHaus standards
Estimated Value for money / return on investment
Reduced Clinical performance
saving heating cost improvement
62 INTERNATIONAL STORIES
Approximate Investment Carbon
Strategy (Capital spending)
Option 1 – DoNothing* Option 2 – Retrofit* ££ üüüü × üü Option 3 – RetrofitExtend* ££££ ü × üüü Option 4 – Newbuild* ££££ × × üüü Option 5 – NewbuildFlex* £££££ ×× × üüüü Figure 4: Estimated relative value for money / return on investment for each strategic option. Figure 5: Comparison of projected 60-year Whole Life Capital Expenditure (£) with WLC (Carbon). DoNothing* (Option 1) Retrofit* (Option 2) RetrofitExtend* (Option 3) Newbuild* (Option 4) NewbuildFlex* (Option 5) 0% 20% 40% 60% 80% 100% 120% 75% 100% 125% 150% 175% Whole Life Carbon (over 60 years) Whole Life £ Expenditure (over 60 years) Whole Life Cost vs Whole Life Carbon (unchanged # clinical activities) Reduced Whole Life Carbon Reduced Whole Life £ Expenditure Increased Whole Life Carbon Increased Whole Life £ Expenditure Reduced Whole Life Carbon Increased Whole Life £ Expenditure
for the new build) to enable internal reconfiguration to meet current healthcare space standards.
• Potential reduction in B6 from improved fabric and systems performance is offset by greater volume of building that needs heating.
• Greater volume of building (to meet healthcare space standards) requires bigger quantity of the improved building systems, which is accompanied by the corresponding higher B4 Replacement Embodied Carbon.
Option 4 – Newbuild*: Demolish and rebuild to the upper limit of PassivHaus and current healthcare space standards.
• Higher A1-A5 reflects the high upfront embodied carbon cost of new-build.
Option 5 – NewbuildFlex*: Like Option 4, but with additional flex in plan space and floor-to-floor heights to facilitate ease of future adaptation.
• B5 refurbishment carbon is reduced, making it an even smaller portion of overall carbon.
Value for money / return on investment
All options other than DoNothing* require additional capital investment, which needs to generate a return. We briefly consider three types of return: environmental (emission reductions); building operations (reduced heating costs), and clinical performance (better outcomes and associated revenue), and these are set out in Figure 4.
Figure 4 shows that Retrofit* likely gives the best carbon value for money. All alternatives to DoNothing* have similar lifetime heating cost, whereas further research is required to establish which option provides the best clinical value for money per £ spent.
Retrofit* is the most financially efficient way of saving whole life carbon emissions, providing the best ‘carbon value for money’, as shown in Figure 5. In fact, NewbuildFlex*
appears to achieve no WLC improvement over DoNothing*. The WLC emissions improvement for Newbuild* is also limited. DoNothing* should not be considered an acceptable option; it delivers no clinical standards improvements, and it will not provide the reductions in operational emissions required from the NHS built estate.
Greater inherent flexibility
There appear to be no net carbon benefits from the greater inherent flexibility of spaces in NewbuildFlex* over NewBuild*. Greater flexibility to reconfigure space in NewbuildFlex* leads to reductions in B5 (embodied carbon from refurbishment), but these are more than reversed by the increases in all other lifecycle modules. This is because a larger building is needed to achieve the flexibility under NewbuildFlex*, which leads to higher emissions in construction (A1-A5), future repair (B3), future component replacements (B4), and heating (B6).
Figure 3 shows that retrofitting – upgrading fabric and changing building systems from gas heating to electric heating – substantially diminishes the overall impact of operational carbon emissions. A phasing out of gas used in other clinical and non-clinical processes in favour of less carbon-intensive electricity should be a priority. We carried out a supplementary study to evaluate whether for Retrofit* and RetrofitExtend* it makes carbon sense to wait until the end of the replacement cycle to replace currently installed heating systems. It does not. All things being equal, the preference in this case is to replace the heating systems as soon as possible to maximise the available operational carbon savings.
In our calculations we have allowed for typical lifespans for systems and products in all options. It is possible, however, that PassivHaus quality standards in RetrofitExtend*, Newbuild*, and NewbuildFlex*, result in systems and products with longer lifespans being selected. We have not allowed for this in our study.
Heating cost return on investment
For all Options, lifetime reductions in heating cost resulting from fabric improvements fall far short from being able to recoup the capital expenditure on these fabric improvements over the life of the building. The reasons for this include:
(1) Whole life heating costs are a relatively small proportion of upfront spend on fabric improvements (see Figures 6 and 7).
Figure 6: Upfront capital cost (fabric and systems, and other) with 60-year lifetime (operational) heating cost.
63 INTERNATIONAL STORIES
£0 £50,000,000 £100,000,000 £150,000,000 £200,000,000 £250,000,000 £300,000,000 DoNothing* (Opt 1) Retrofit* (Opt 2) RetrofitExtend* (Opt 3) Newbuild* (Opt 4) NewbuildFlex* (Opt 5) Operational heating costs Return on capital spend on fabric, systems Up-front £ capital cost (all other) Up-front £ capital cost (fabric, systems) Whole life £ operational heating cost
(2) A switch from inefficient gas to more efficient electricity (with fabric upgrades) has a small impact on heating costs because of the continued low price of gas compared with electricity (see Figure 7). We have based this analysis on gas and electricity price projections by BEIS and the European Commission, assuming no future carbon taxes. Different assumptions may alter these conclusions.
DoNothing* has the least efficient building fabric and systems, and is heated by carbon-intensive gas. Figure 7 shows how the whole life (operational) heating cost picture is distorted in favour of DoNothing*, because gas is substantially cheaper than electricity per kWH. A regulated minimum gas price to favour electric heating and a tax on carbon emissions may help drive demand away from the use of gas for heating. For these reasons, reduced heating costs are currently not a
likely avenue for financially recouping investment in fabric and systems improvements. Instead, the financial returns of such capital investment are likely to come through improved clinical outcomes. This is discussed in the next section.

Clinical return on investment
A study of clinical outcomes at FCBStudios’ Dyson Centre for Neonatal Care found that better lighting, air quality and temperature, space configuration and finishes in the new building resulted in improved wellbeing of staff, babies, and mothers. Babies slept 7% more on average. Although not measured in the study, it is reasonable to assume that these shortened lengths of stay translated to greater patient throughput, more clinical activities being performed, and increased revenue.


Whole Life Carbon
Whole Life Cost
DoNothing*
1)
2)
3) Newbuild* (Opt 4) NewbuildFlex* (Opt 5)
Embodied
Maintenance+Repair
(Embodied)
Operational
Figure 7: Split between lifecycle modules (projected 60-year). Left: Whole Life Carbon. Right: Whole Life Cost (£). The carbon impact of operational energy is much greater than the cost impact (represented by the yellow bars on the charts).
FCB Studios’ retrofit of Senate House at the University of Bristol saved approximately two-thirds of the upfront embodied carbon over the new-build alternative. (Image credit: Rebecca Noakes Photography.)
FCBStudios’ Dyson Centre for Neonatal Care in Bath. (Photo credit: Craig Auckland / fotohaus).
FCBStudios’ retrofit of the Richmond Building at University of Bristol saved approximately two thirds of the upfront embodied carbon over the new-build alternative. (Image credit: Hufton & Crow).
64 INTERNATIONAL STORIES
50,000,000 100,000,000 150,000,000 200,000,000 250,000,000 DoNothing* (Opt 1) Retrofit* (Opt 2) RetrofitExtend* (Opt 3) Newbuild* (Opt 4) NewbuildFlex* (Opt 5)
A1-A5 Upfront Embodied B3+B3 Maintenance+Repair (Embodied) B4 Replacement (Embodied) B5 Refurbishment (Embodied) B6 Operational £0 £200,000,000 £400,000,000 £600,000,000 £800,000,000 £1,000,000,000
(Opt
Retrofit* (Opt
RetrofitExtend* (Opt
A1-A5 Upfront
B3+B3
(Embodied) B4 Replacement (Embodied) B5 Refurbishment
B6
The same is likely for our London NHS hospital study: Improvements to air quality, temperature, and natural light (achieved with all options other than DoNothing*) and space standards (RetrofitExtend*, NewBuild* and NewbuildFlex*) are all expected to improve patient, staff, and visitor wellbeing, and shorten times to discharge. Again, shorter stays likely result in greater throughput, capacity, and therefore income to the Trust. We estimate that the upfront capital cost of Retrofit* could be earned back over 60 years if it leads to an overall reduction of approximately 1-2% in length of stays. Anything better than this should result in a shorter break-even period and a positive return on capital invested in Retrofit*.
A note on COVID
COVID and the possibility of similar pandemics in future has underscored the need for:
• Better achieved with the building systems modifications of all options other than DoNothing*.
• Social distancing, which can be more easily achieved under the improved space standards of RetrofitExtend*, NewBuild*, and NewbuildFlex*.
• Flexible layouts that can respond effectively to changing infection control requirements, best delivered via NewbuildFlex*.
These principles seem to indicate that NewbuildFlex* is the most attractive from the perspective of managing Covid, but this needs to be considered in conjunction with all types of returns (including environmental, operational, and clinical).
Summary and further discussion
The relative importance of the three return types in the table at the start of this section (carbon emissions, heating costs and clinical emissions) will help inform the Trust’s preferred strategic option. Whether the escalation of the climate emergency will in time make clinical space standard upgrades of RetrofitExtend*, NewBuild*, and NewbuildFlex*sufficiently unaffordable financially (likely soon through e.g., carbon taxes and other emissions disincentives) remains to be seen.
The substantial upfront embodied carbon associated with the new-build options to improve quantitative clinical space standards (RetrofitExtend*, NewBuild*, and NewbuildFlex*) work against their ability to support the UK’s overall 2030 and 2035 carbon reduction targets vis-à-vis DoNothing* and Retrofit* with low upfront carbon emissions.
Innovation must turn to how achieve more (clinically) with less (spatially). Solutions will range from smart retrofit of existing buildings that spare the embodied carbon of new build, to healthcare innovations, moving activities to lower acuity settings (such as polyclinics or the home), smart timetabling, flexible zoning, providing slack space for space standard upgrades without the need for new-build and technology improvements.
Based on our findings, we propose that as a rule of thumb, new-build should be reserved for high acuity functions
FCBS Carbon
FCBS Carbon is a tool which can be used to calculate a project’s whole life carbon. A free version of the tool is available at https://www.fcbstudios.com/Climate/ Detail?name=fcbs-carbon
Part Z
Part Z (www.part-z.uk) is a proposed amendment to the Building Regulations, to mandate the re-porting of whole life carbon and set limits for up-front embodied carbon. FCBStudios is a central supporter of this initiative.
that have unique requirements unable to be met by existing building stock. These requirements, for say theatres, imaging, and intensive care, would include deep service zones, longer spans, high load capacities, and low vibration tolerances. All other accommodation should be provided in existing buildings, retrofitted as necessary, as far as possible. We recommend that this proposal is incorporated as strategic guidance in the next version of the Delivering a ‘Net Zero’ National Health Service document.
Concluding thought
Reducing carbon and improving clinical standards are two key priorities of a health Trust. Meeting the UK’s and NHS’s emissions targets requires an earnest emphasis on building retrofit (Retrofit*, Option 2). Although building retrofit may currently not always be the preferred option to produce optimal clinical outcomes, urgent research and innovation is needed to ensure that future clinical and care improvements do not come at the cost of high carbon emissions.
References
1 Delivering a ‘Net Zero’ National Health Service. NHS England, October 2020. https://tinyurl.com/2p9bbw29
2 Part Z: A proposed amendment to UK Building Regulations 2010 20 July 2021. www.part-z.uk
3 See: UK enshrines new target in law to slash emissions by 78% by 2035. Department for Bu8sness, Energy & Industrial Strategy press release, 20 April 2021.
4 The IPCC’s Special Report, Global Warming of 1.5 °C, 2021, assesses the potential impacts of an average global warming of 1.5 °C and 2 °C on climate, human, and eco-systems. Higher global temperatures increase the probability of these systems crossing ‘tipping points’, defined as ‘thresholds beyond which certain impacts can no longer be avoided even if temperatures are brought back down later on’. www.ipcc.ch/sr/15/
5 Page 14 of Delivering a ‘Net Zero’ National Health Service. NHS England, October 2020. https://tinyurl.com/2p9bbw29
This article first appeared in Health Estate Journal, the monthly magazine of the Institute of Healthcare Engineering and Estate Management (‘IHEEM’)
65 INTERNATIONAL STORIES

DECONTAMINATION INFECTION RISKS AND THE ENVIRONMENT
Dr Mark Garvey at CSC
The healthcare environment continues to present a risk of infection transmission, so what can we do to protect patients in a post-pandemic era? The Central Sterilising Club’s 60th anniversary annual scientific meeting showcased the latest evidence for best practice, highlighting some of the potential threats that need to be addressed.
Environmental
decontamination was high on the agenda at the Central Sterilising Club’s annual scientific meeting – the pandemic has intensified interest in technologies that tackle airborne pathogens, but the familiar foes of Methicillin-resistant Staphylococcus aureus (MRSA), Clostridium difficile (C.difficile) and vancomycin-resistant enterococci (VRE) (to name just a few) still remain a challenge. While technologies such as hydrogen peroxide vapour (HPV) and ultraviolet (UV) have an important role in helping to prevent healthcare-associated infections, cleaning is still fundamental to ensure patient safety and to reduce the risk of environmental transmission. But do we give this the training or recognition it deserves?
Dr. Mark Garvey, consultant clinical scientist in microbiology and deputy director of infection prevention and control at University Hospitals Birmingham NHS Foundation Trust (UHB), tackled this issue in a presentation on ‘Wiping out Infections’.
“In healthcare, we are undertaking increasingly complicated work, especially at the University Hospitals Birmingham, one of the largest hospitals in the UK – with over 2,500 beds. We perform transplants every day and put lots of devices into patients, which can provide potential routes into patients for microorganisms,” he commented.
Eliminating these microorganisms in the environment is key to patient safety. Garvey highlighted a Ted Talk by Jack Gilbert on “The microbiome revolution: why microbes control your life”1 which highlights just how many microorganisms we expel into the environment at any one time. Gilbert points out that around 100 trillion cells in your body are bacterial and only 10 trillion are human – which means you are “outnumbered 10:1 by microbial cells”.
Presenting some worrying examples of infection risks in healthcare settings, Garvey commented that it is easy to see how the environment can play an important role in the transmission of microorganisms. Some of the photos
presented during his talk showed evidence of visible faecal matter in healthcare settings, underscoring the importance of environmental cleaning.
He explained that pathogens can survive for long periods in the environment –for example, S. aureus (including MRSA) can last from 7 days to >12 months; Enterococcus spp. (including VRE) for 5 days to >48 months; C.difficile (spore form) for >5 months; and Acinetobacter spp. for 3 days to 11 months (Dancer et al, 2014).2 Garvey added that some microorganisms can also survive in ‘protective’ biofilms in the environment making them even more challenging.

Various studies have looked at organism transfer in clinical environments. One study, by Oelberg et al (2000),3 involved the inoculation of non-infectious cauliflower mosaic virus DNA into a phone in a neonatal unit ICU cubical. The virus spread to 58% of ward sampling sites within seven days of inoculation – spreading to all five other cubicles, contaminating the doorhandles first.
A paper by Otter et al (2013)4 highlighted an increased risk of acquiring an infection from the prior room occupant (as high as 71%, if the prior patient had A. baumannii). In addition, a prospective cohort study in an ICU, by Nseir et al (2011),5 also found that successive occupiers of a room are at risk from organisms from previous occupants. Quality audits showed that 56% of rooms were not cleaned correctly –
67 INTERNATIONAL STORIES
failures were highest for door handles (45%), monitor screens (27%) and bedside tables (16%).
Cleaning is vital and yet it is either carried out by low paid staff of low status who have been trained, or well-paid staff of higher status, who have not been trained.

Garvey pointed out that a longer clean is not necessarily a more effective clean, while systems to monitor cleaning are often ineffective or absent.
“When healthcare practitioners undertake their degrees, how much training do they have around cleaning and its importance – particularly around the science and the reasons why we do what we do?” he commented. “Cleaning is a science and we’re trying to get people’s attention. But how much do we teach people on the fundamentals?”
When there are outbreaks, there is a tendency to shift the responsibility onto facilities and, in general, there is confusion over the division of labour.
To tackle this confusion, a schematic of the categories of cleaning has been developed at University Hospitals Birmingham – from green, amber and red cleans, through to platinum and violet cleans – depending on the infectious status and pathogens involved.
Green cleans, for example, are performed by clinical/ward staff using Clinell wipes, following the discharge of patients (with no known infection and no diarrhoea); platinum cleans are carried out by facilities, following the discharge of patients with Carbapenemase Producing Enterobacteriaceae (CPE) or multi-drug resistant Acinetobacter, and involve a steam clean, Chlor-cleaning, HPV misting and curtain change. Violet cleans are also performed by facilities and involve Chlor-cleaning and curtain changes but use a UV-machine in areas where HPV cannot be used. Pre-cleaning, prior to amber, red, platimum and violet cleans, is performed by the clinical/ward staff.

Garvey commented that, over recent years, wipes have become firmly established in clinical areas in the UK and other countries. They are used on patients, equipment (from nasendoscopes to commodes), and the environment for cleaning and/or disinfection. The advantages are they are convenient and can be placed at the point of care and they are pre-mixed and pre-measured.
Birmingham previously used a two-stage wipe and instructed nursing staff to use the detergent clean, followed by the disinfection clean.
“When we actually went on to the wards and looked at this, most people would just use the disinfection wipe as the alcohol smelt more potent. However, this fixes things to the surface,” Garvey explained. “Often, staff were not using the detergent wipe. So, we moved to the single-stage Clinell wipes, which contain a surfactant that is good for cleaning. They also contain a disinfectant. When we moved to the one-wipe system, we saw a significant reduction in MRSA acquisition.” (Garvey et al, 2018)6 This was due to the fact that the system made cleaning much easier for staff.
68 INTERNATIONAL STORIES
Garvey explained that funding was obtained to take samples to identify microorganisms with the Medical Assessment Unit (MAU) and to examine the cleaning protocols. Environmental samples were taken by swabbing seven high-touch sites, such as the bed rail, patient armchair, patient chair seat, patient table (overside and underside), patient locker and nurse call button. The study looked at the total viable counts before and after cleans. The key takehome message was that the actual physical (green) clean, using Clinell wipes, achieved a significant log reduction in microorganisms in the environment, when performed properly. However, green cleans were often missed.
“The first clean is vitally important. HPV and UV won’t work unless you do a good physical clean in the first instance,” he commented. He explained that the study initially found C.difficile in the MAU environment; after the green clean, it could no longer be found. Garvey suggested that this was due to the physical removal of the spores. However, an important aspect was also the education provided – when education stopped, C.difficile increased; when it was restarted, it went back down.
Garvey went on to highlight an analysis of a randomised controlled trial (RCT) by Anderson et al (2017)7 which assessed four different strategies for terminal room disinfection. The study found that enhanced terminal room cleaning with UV in high-risk rooms led to a decrease in hospital-wide incidence of C.difficile and VRE.
“UV is very effective and is very quick as well,” Garvey commented, adding that it won’t be effective if the room is cluttered with lots of equipment, however, as this will create shadows.
University Hospitals Birmingham sought to tackle VRE on its ITU and liver wards, following some outbreaks, which prompted the purchase of a UV machine. Since the introduction, levels have plummeted.

He went on to highlight a paper, which looked at Pseudomonas aeruginosa infection in augmented care areas, in four large UK hospitals (Halstead et al, 2021).8
Over a 16-week period, all water outlets in augmented care units of four hospitals were sampled for Pseudomonas aeruginosa (P. aeruginosa) and clinical isolates were collected. The outlet and clinical isolates underwent whole-genome sequencing (WGS).
Outlets were positive in each hospital and there were 51 persistently positive outlets in total. WGS identified likely transmission from outlets to patients in three hospitals for P. aeruginosa positive patients. Approximately 5% of patients in the study ‘definitely’ acquired their P. aeruginosa from their water outlets in the intensive care unit. Extensive evidence of transmission was found from the outlet to the patients particularly in the newest hospital, which had the highest rate of positive outlets.
The overall findings suggest that water outlets are the most likely source of P. aeruginosa nosocomial infections in
some settings, and that widespread introduction of control measures would have a substantial impact on infections.
Garvey showed a photo of a sink with paper towels on the floor, surrounding the area, to demonstrate just how far water is dispersed in the room, as well as an image of a water droplet on impact – highlighting the potential spread and trajectory of waterborne pathogens in aerosols.
Garvey went on to explain how can we tackle the risk of Pseudomonas aeruginosa, from an engineering perspective, highlighting a paper co-authored with Christina Bradley, among others, which looked at possible interventions on a critical care unit.
Water sampling undertaken on the ICU indicated 30% of the outlets were positive for P. aeruginosa at any one time. Molecular typing of patient and water isolates via Pulsed Field Gel Electrophoresis suggested there was a 30% transmission rate of P. aeruginosa from the water to patients on the ICU.
From February 2014, QEHB implemented engineering interventions, consisting of new tap outlets and PALL point-ofuse filters; as well as holistic measures, from February 2016, including a revised tap cleaning method and appropriate disposal of patient wastewater. Breakpoint models indicated the engineering and holistic interventions resulted in a significant (p<0.001) 50% reduction in the number of P. aeruginosa clinical patient isolates over a year.9 Garvey pointed out that appropriate management of water, including both holistic and engineering interventions, is needed to stop transmission of P. aeruginosa from water to patients. The disposal of patient wastewater, cleaning of tap outlets, and cleaning of medical equipment all need to be considered, along with engineering solutions.
“We had three patients who had central line infections involving P. aeruginosa. When we looked at this, they all had the same type. The tap in the IV prep room did not have a Pall filter and the infusion therapy procedure trays were being
69 INTERNATIONAL STORIES
INTERNATIONAL
washed in the water… This shows the importance of teaching staff about cleaning,” Garvey explained.10
Garvey further highlighted new guidelines on automated room decontamination published by a Healthcare Infection Society Working Party.11 The document states that “good practice” includes:
• Manual cleaning should be completed to the same high standard regardless of the subsequent use of automated cleaning devices.
• On first use of a fumigant or ultraviolet light in a specific room design, efficacy of sealing should be monitored to ensure safety.
• Prioritise different cleaning systems to the type of infection of the most recent room occupant by use of a red/ amber/ green rating based on local nosocomial infection rates.
• Remove foam materials from the room if fumigant is used unless sealed under an impervious cover.
• Before purchasing or renting a system, run a mock decontamination cycle in a hospital room to determine turn-around times.
• After purchasing an ultraviolet-light decontamination system, consider the impact on surface finishes such as whitened polyvinyl chloride (PVC) before purchasing other equipment, and ask the equipment supplier to confirm compatibility.
• Monitor levels of fumigant or ultraviolet light at regular intervals during the contract to ensure efficacy.
• When adopting a new automated system or disinfecting a new room design, conduct microbiological culture tests (if permitted in the hospital) or take in-use environmental swab tests before and after disinfection to confirm efficacy. Ultimately, he argued that cleaning is a science, and it is time to recognise it as such. We need to change the language – instead of saying “has that been cleaned?”, we should say “is that room/piece of equipment safe?” Garvey stated that nursing staff need to be educated in the importance of cleaning, while solutions need to be simple – such as changing over to more practical wipes. New technologies, such as UV, can help, as the latter is quick and can help hospital flow, but we also need to consider human factors.
“You need to ask yourself, would you have your mum or loved one go into that room? This is how I broach my outbreak meetings,” he concluded.
At the end of his presentation, Garvey announced that a new PhD has been launched in Christina Bradley’s memory, sponsored by Gamma. Tina was a committee member of the CSC in various positions culminating in being Chair between 2014-17 and was awarded Honorary Life Membership for her significant contributions to the organisation. Her work was well known to the healthcare community, and she provided an enormous contribution to improving overall standards in all areas of decontamination practice. CSJ
For CSC membership please contact: membership@centralsterilisingclub.org
References
1 Gilbert, J, The microbiome revolution: why microbes control your life, Ted Talks, Accessed at: https://www.youtube.com/ watch?v=aksMWePT6XQ
2 Dancer SJ. Controlling hospital-acquired infection: focus on the role of the environment and new technologies for decontamination. Clin Microbiol Rev. 2014 Oct;27(4):665-90. doi: 10.1128/ CMR.00020-14. PMID: 25278571; PMCID: PMC4187643.
3 Oelberg DG, Joyner SE, Jiang X, Laborde D, Islam MP, Pickering LK. Detection of pathogen transmission in neonatal nurseries using DNA markers as surrogate indicators. Pediatrics. 2000 Feb;105(2):311-5. doi: 10.1542/peds.105.2.311. PMID: 10654947.
4 Otter JA, Yezli S, Salkeld JA, French GL. Evidence that contaminated surfaces contribute to the transmission of hospital pathogens and an overview of strategies to address contaminated surfaces in hospital settings. Am J Infect Control. 2013 May;41(5 Suppl):S6-11. doi: 10.1016/j.ajic.2012.12.004. PMID: 23622751.
5 Nseir S, Blazejewski C, Lubret R, Wallet F, Courcol R, Durocher A. Risk of acquiring multidrug-resistant Gram-negative bacilli from prior room occupants in the intensive care unit. Clin Microbiol Infect. 2011 Aug;17(8):1201-8. doi: 10.1111/j.14690691.2010.03420.x. Epub 2010 Dec 13. PMID: 21054665.
6 Garvey MI, Wilkinson MAC, Bradley CW, Holden KL, Holden E. Wiping out MRSA: effect of introducing a universal disinfection wipe in a large UK teaching hospital. Antimicrob Resist Infect Control. 2018 Dec 19;7:155. doi: 10.1186/s13756-018-0445-7. PMID: 30574298; PMCID: PMC6299988.
7 Anderson DJ, Chen LF, Weber DJ, Moehring RW, Lewis SS, Triplett PF, Blocker M, Becherer P, Schwab JC, Knelson LP, Lokhnygina Y, Rutala WA, Kanamori H, Gergen MF, Sexton DJ; CDC Prevention Epicenters Program. Enhanced terminal room disinfection and acquisition and infection caused by multidrug-resistant organisms and Clostridium difficile (the Benefits of Enhanced Terminal Room Disinfection study): a cluster-randomised, multicentre, crossover study. Lancet. 2017 Feb 25;389(10071):805-814. doi: 10.1016/ S0140-6736(16)31588-4. Epub 2017 Jan 17. PMID: 28104287; PMCID: PMC5935446.
8 Halstead FD, Quick J, Niebel M, Garvey M, Cumley N, Smith R, Neal T, Roberts P, Hardy K, Shabir S, Walker JT, Hawkey P, Loman NJ. Pseudomonas aeruginosa infection in augmented care: the molecular ecology and transmission dynamics in four large UK hospitals. J Hosp Infect. 2021 May;111:162-168. doi: 10.1016/j.jhin.2021.01.020. Epub 2021 Feb 1. PMID: 33539934.
9 Garvey MI, Bradley CW, Wilkinson MAC, Bradley C, Holden E. Engineering waterborne Pseudomonas aeruginosa out of a critical care unit. Int J Hyg Environ Health. 2017 Aug;220(6):1014-1019. doi: 10.1016/j.ijheh.2017.05.011. Epub 2017 May 31. PMID: 28592358.
10 Garvey MI, Bradley CW, Holden E. Waterborne Pseudomonas aeruginosa transmission in a hematology unit? Am J Infect Control. 2018 Apr;46(4):383-386. doi: 10:1016/j.ajic.2017.10.013. Epub 2017 Nov 28. PMID: 29195780.
11 Beswick AJ, Fry C, Bradley CR, Pottage T, Sharpe S, Haill CF, Mugglestone MA, Bak A, Marsden GL, Bennett A, Garvey M, Wilson APR. Automated room decontamination: report of a Healthcare Infection Society Working Party. J Hosp Infect. 2022 Jan 24:S0195-6701(22)00011-1. doi: 10.1016/j.jhin.2022.01.006. Epub ahead of print. PMID: 35085677.
This article first appeared in The Clinical Services Journal, June 2022.
70
STORIES
PD DAY FOCUSING OF INSTALLATION OF MEDICAL IMAGING EQUIPMENT INTO HOSPITAL

Held on the 2nd of Sept 2002 at the office of ACIA Electrical Services Pty Ltd in Caringbah NSW.
Speakers for the 2 hr event:
• Katie Reidpath, project manager Siemens Healthineers
• Cameron Ivers ACIA Electrical Services Pty Ltd, IHEA NSW/ACT committee member.
• David Van Dorssen- Morsens. Medical equipment installer
• Jon Morgan- Morsens. Builder/ construction in the medical field.
Having the suppliers project management side, the medical installer, the builder and the electrician all discussing the processes of delivering the complete package of installing medical equipment to hospitals. Also having issues raised from facility managers, explaining their concerns. Great, where the crew on the ground from all sides having and open discussions. Great to see the perspective from each group involved.
From access, delivery path, structural issues, lighting, hepa filters, mechanical services, uni-strutt, electrical supplies, body/ cardiac protect, noise complaints, inductions, MRI cages, UPS, generator supplies and many other items were discussed.
Thanks for all involved.
For any queries email Cameron cameron@aciaelectrical.com.au

EVIDENCE-BASED DESIGN STERIL-AIRETM GERMICIDAL UVC DELIVERS A 6 LOG
MICROBIAL LOAD REDUCTION, IMPROVES NICU OUTCOMES
A newly published peer-reviewed abstract1 documents the effectiveness of Steril-Aire UVC Emitters in reducing ventilator-associated pneumonia (VAP) in a neonatal intensive care unit (NICU).

The study was performed at the Buffalo Department of Pediatrics, Neonatology, Women and Children’s Hospital of Buffalo (NY) over 2.5 years. The microorganisms found in the HVAC system included Pseudomonas, Klebsiella, Serratia, Acinetobacter, Staphylococcus aureus and Coagulasenegative Staphlococcus species. The study concluded that Steril-Aire germicidal UVC “eradicated microbes in HVAC systems and was associated with a decrease in NICU environmental pathogens and tracheal colonization.” The study showed a greater than 6 Log (that’s 99.9999%) microbial load reduction per square centimetre of HVAC coil in just 6 days!
Study Conclusions: The study determined that UVGI decreased HVAC microbial colonization with significant reductions in VAP due to a decrease in NICU environmental pathogens and tracheal colonization. The study finding also included a decrease in antibiotic use in NICU high-risk patients.
VAP, the second most common hospitalacquired infection among pediatric intensive care unit (PICU) patients, is responsible for an increased length of stay and an attributable health-care cost estimated at over $30,000. VAP has also been associated with the emergence of antibiotic-resistant microorganisms.
With the NICU implementation of Steril-Aire UVC, the Women and Children’s Hospital of Buffalo has realized an $800,000/year reduction in direct costs and a $1.7 million/year reduction in 3rd party charges.
And, considering the fact that VAP has a mortality estimated to be as high as 27.1%, the Steril-Aire solution is literally ... priceless.

1. Journal of Perinatology (2011), 1-8
The full peer-reviewed, Medical Journal published study is available from Steril-Aire Oceania. info@steril-aire.com.au.
Phone 1300 781 128

71 NEWS
NATURAL TECHNOLOGY
You might already be aware of the multitude of applications for which steam is used to provide thermal energy; space heating, domestic hot water, humidification, sterilisation, cooking, laundry and a great many other processes and purposes. With so many uses across an array of industries, what relationship does steam have with sustainability? It may surprise you to learn that Spirax Sarco estimates that customers using a range of Spirax Sarco products, services, and solutions were able to directly reduce their annual emissions by around 15.8m tonnes of CO2 – equivalent to removing 7.7million cars from the road. As we look forwards to the next generation of technology tasked with delivering steam, carbon reduction is set to improve as we begin embracing the use of innovative, low-carbon methods of steam production, some of which we explore later. Steam itself is a very clean and natural media – it is, after all, simply water vapour. When it has given up its’ thermal energy, it condenses back to water and can be reused. When generated under pressure, it can be compressed into smaller pipework and equipment than other heat transfer media and does not require distribution pumping. Steam is very ‘energy dense’, and therefore, it is a hugely efficient carrier and instantaneous provider of thermal energy within a much-reduced mass flow compared to other solutions. It also offers us the opportunity for very precise temperature control and with better control comes improved energy efficiency and reliable performance.
Spirax Sarco products, services and solutions were able to directly reduce their annual emissions by around 15.8m tonnes of CO2

“
NEW STEAM GENERATION TECHNOLOGIES‘CONCEPTS OF TODAY’ ARE BECOMING ‘THE REALITY OF TOMORROW’

If you follow developments in relation to new technologies generally, you’ll doubtless be aware of how quickly things move. Similarly, within the area of sustainability technologies, this is increasingly so with hundreds of funded Hydrogen research projects, Carbon Capture, Floating Wind Farms and Nuclear Fusion Reactors, to name but a few. All are, of course, aligned to the goal of the sustainable provision of energy, in particular electricity. With the progression towards electric vehicles, digitisation (including the steam plant) and increased electrification across all sectors, there are clear challenges ahead both nationally but also locally (at the site level) regarding electrical infrastructure. Our ability to generate and utilise as much energy as possible from renewable or off-peak sources is likely to be an essential aspect of any longer-term Net Zero Strategy. Balancing the availability of electricity with the demand for thermal energy will become increasingly important, so if we can store energy efficiently for later use, then this will be a huge benefit. In support of these aims, Spirax Sarco is delighted to be in the later phases of development (with a number of trial sites already active) with two key enabling technologies – the electrification of steam boilers and also our Thermal Store.
https://www.spiraxsarco.com/global/en-AU/contact-us

PREPARING FOR THE ESTATE OF THE FUTURE, THE DECARBONISATION OF STEAM GENERATION AND STEAM DISTRIBUTION FOR CRITICAL STEAM USERS
“
BOILER ELECTRIFICATION
Our DirectConnect™ innovation has been developed in order to achieve complete electrification of steam boilers. Until recently, electrical steam generation was almost exclusively focused on lower outputs of steam. Now it is possible to achieve outputs far in excess of this, in fact, at or above the output typically seen from a traditional gas-fired steam boiler. Whether it be as a direct boiler replacement or capacity for resilience purposes, or as a top-up thermal supply to supplement other technologies, the instantaneous generation of as much as 20,000 kg/hr of steam using sustainable sources of energy to implement electrification of steam boilers is now becoming a reality. In addition to this, sites should consider employing Thermal Storage as an efficient means of smoothing the demands placed on infrastructure.
THERMAL STORAGE
Whether future plans include outsourced or on-site renewables, or perhaps there is likely future strain on electrical infrastructure, it is highly likely that any ‘mixed method system’ will need to be balanced and optimised to ensure the availability of energy and its’ consumption are best aligned. The Spirax Sarco Thermal Store offers a solution to these challenges. With a much longer expected lifecycle and a far higher energy density than many other storage solutions, along with almost no performance degradation over time, the Thermal Store is becoming a key enabling technology allowing estates to harness electrical energy (however provided), converting this directly to stored thermal energy. When it comes to balancing out the demands on electrical infrastructure, de-coupling the availability of renewable energy from the demand for it to be used, or the need for resilience or top-up capacity, we can start to appreciate how the Spirax Sarco Thermal Store will help deal with the challenges faced by many sites.


CONCLUSION & NEXT STEPS
Steam is a highly efficient media for the transfer of thermal energy, with some huge advantages over other solutions. It also possesses some great ‘green credentials and is a naturally occurring fluid. As we further develop and refine the sustainable generation and storage of steam, this will open up a great many opportunities for the use of steam to remain an integral part of the solutions we use in order to achieve Net Zero. Spirax Sarco is ideally placed to harness its extensive knowledge, experience and resources in order to support you in measuring, assessing, evaluating and optimising your existing steam system. Whether it be metering and monitoring, or auditing and reporting, we can identify, propose, and produce a wide range of optimisation solutions and services to support you and to make an immediate impact on reducing carbon emissions. We can work with you and alongside your Estates, Energy & Sustainability and other stakeholder teams in order to incorporate sustainable steam technologies to help you deliver a safe, sustainable, resilient and efficient system for the longer term. With our extensive range of aftercare services we can provide the support you want long after any installation is completed. If you’d like to find out more about making your journey towards Net Zero with steam and Spirax Sarco, then please get in touch and we’d be delighted to explore these opportunities with you in more detail.
https://www.spiraxsarco.com/global/en-AU/contact-us




Healthcare solutions + Clean Steam Solutions + Steam Quality and Purity Testing + Steam Systems Optimisation + Instantaneous Hot Water Generation + Steam System Services Steam System Audits | Installation & Commissioning | Service & Repair For more information contact Spirax Sarco on 1300 774 729 (SPIRAX) or info@au.spiraxsarco.com CSG HS Clean Steam Generator Steam Quality testing EasiHeatTM Instantaneous Hot Water Generation












